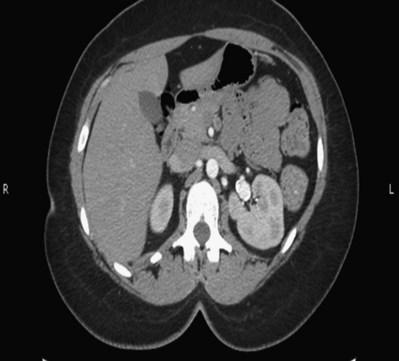
image

chapter 54 Contemporary Open Surgery of the Kidney
History
The history of open renal surgery is characterized by the spirit of innovation, investigation, and excellence that distinguishes modern urology (Table 54–1). Despite progress in minimally invasive techniques and other alternatives, open renal surgery remains a vital field that continues to benefit from refinement and research. Open surgery is an essential component of the contemporary, cutting-edge surgical armamentarium.
Table 54–1 Important Advances in Open Renal Surgery
| YEAR | INNOVATION |
|---|---|
| 1869 | Gustav Simon performed the first nephrectomy in a human to treat a ureterovaginal fistula, after first demonstrating that dogs are able to survive with a solitary kidney (Simon, 1870). |
| 1878 | Kocher and Langham use a midline incision to accomplish an anterior transperitoneal nephrectomy (Kocher and Langham, 1878). |
| 1881 | Morris performed the first nephrolithotomy (Morris, 1881). |
| 1884 | Wells performed an inadvertent partial nephrectomy while removing a perirenal fibrolipoma (Wells, 1884). |
| 1887 | Czerny carried out the first planned partial nephrectomy to treat a renal tumor (Herr, 2008). |
| 1891 | Kuster completed the first successful dismembered pyeloplasty (Kuster, 1896–1902). |
| 1903 | Grégoire performed the first procedure resembling a radical nephrectomy, described as an en-bloc resection of a kidney, perirenal fat, adrenal gland, and lymphatic tissue for cancer (Grégoire, 1903). |
| 1913 | Berg employed a transverse abdominal incision and mobilization of the colon to safely control the renal pedicle. He also obtained control of the renal veins and made a cavotomy to extirpate caval tumor thrombi (Berg, 1913). |
| 1922 | Rehn performed caval resection with reimplantation of the contralateral renal vein (Rehn, 1922). |
| 1932 | Rosenstein performed a palliative partial nephrectomy for renal cancer in a patient with contralateral renal insufficiency, defining an indication for nephron-sparing surgery (Rosenstein, 1921). |
| 1959, 1960 | Kerr and Klotz described renal hypothermia to minimize ischemic damage while prolonging available operative time for partial nephrectomy (Kerr et al, 1960; Herr, 2008). |
| 1973 | Libertino and Zinman described revascularization of the totally occluded renal artery (Zinman and Libertino, 1973). |
| 1998 | Libertino described use of a minimally invasive approach for cardiopulmonary bypass for vena cava thrombectomy (Fitzgerald et al, 1998). |
Surgical Anatomy
General
Knowledge of regional anatomy is vital to safe and efficient renal surgery (Figs. 54-1 to 54-4 on the Expert Consult website![]() ). The renal capsule, perinephric fat, Gerota fascia (renal fascia), and paranephric fat are important landmarks in staging and surgery of renal malignancy (see Fig. 1–27).
). The renal capsule, perinephric fat, Gerota fascia (renal fascia), and paranephric fat are important landmarks in staging and surgery of renal malignancy (see Fig. 1–27).
Renal Vasculature
Arterial
The origin of the right renal artery is beneath the left renal vein and it typically passes posterior to the inferior vena cava (IVC) (Fig. 54–5; see also Fig. 1–33). During transabdominal left radical nephrectomy, knowledge of this anatomic relationship may prevent inadvertent ligation of the right renal artery (Fig. 54–6; see Fig. 54–7 on the Expert Consult website![]() ). The inferior adrenal artery and a branch that supplies the renal pelvis and ureter arise from the renal artery. In the majority of cases the renal artery branches in the distal third of the vessel or the renal sinus.
). The inferior adrenal artery and a branch that supplies the renal pelvis and ureter arise from the renal artery. In the majority of cases the renal artery branches in the distal third of the vessel or the renal sinus.

Figure 54–5 Arterial anatomy can be well defined using CT (A) and three-dimensional reconstruction (B).

Figure 54–6 Relationship of right kidney to great vessels. IVC, inferior vena cava; Ao, aorta.
(© The Lahey Clinic.)

Figure 54–7 Vessel loops isolate right renal artery (red) at take off from aorta. The left renal vein (blue) is mobilized cephalad to divide the right renal artery near the aorta.
The kidney is divided into four segments (superior, anterior, posterior, inferior) that are supplied by one or more segmental renal arteries, which are end arteries (Fig. 54–8 on the Expert Consult website![]() ). Ligation or occlusion of a segmental artery, or any of its branches, leads to devitalization of renal tissue. Intraoperatively, one can administer methylene blue dye and occlude the segmental arteries to define the borders of the vascular segments. Despite variation in the origin of the branches supplying the renal segments, the anatomic pattern of the segments is constant (Graves, 1954). Three planes between the vascular segments can be demonstrated (see Fig. 54–8 on the Expert Consult website
). Ligation or occlusion of a segmental artery, or any of its branches, leads to devitalization of renal tissue. Intraoperatively, one can administer methylene blue dye and occlude the segmental arteries to define the borders of the vascular segments. Despite variation in the origin of the branches supplying the renal segments, the anatomic pattern of the segments is constant (Graves, 1954). Three planes between the vascular segments can be demonstrated (see Fig. 54–8 on the Expert Consult website![]() ) and are important for intrarenal surgery. In theory, incision in the plane between the anterior and posterior segments affords reduced blood loss (Brodel, 1900) and has been described for anatrophic nephrolithotomy (Smith and Boyce, 1968). This plane, located on the posterior surface of the kidney, is not to be confused with the “Brodel white line,” a whitish linear depression on the lateral aspect of the anterior surface of some kidneys formed by fusion of anterior and posterior columns of Bertin, which demarcates a highly vascular area (Brodel, 1900) (Fig. 54–9).
) and are important for intrarenal surgery. In theory, incision in the plane between the anterior and posterior segments affords reduced blood loss (Brodel, 1900) and has been described for anatrophic nephrolithotomy (Smith and Boyce, 1968). This plane, located on the posterior surface of the kidney, is not to be confused with the “Brodel white line,” a whitish linear depression on the lateral aspect of the anterior surface of some kidneys formed by fusion of anterior and posterior columns of Bertin, which demarcates a highly vascular area (Brodel, 1900) (Fig. 54–9).
Typically, the first division of the renal artery creates the anterior and posterior segmental branches (see Fig. 1–30A and B). The posterior segmental branch of the main renal artery arises proximal to the hilum, passes posterior to the renal pelvis, and supplies the posterior renal segment. Classically, a crossing vessel responsible for ureteropelvic junction (UPJ) obstruction is an aberrant posterior segmental artery passing anterior to the UPJ. The anterior segmental branch of the main renal artery divides into four divisions: the apical (superior) segmental artery, the anterior superior segmental artery, the anterior inferior segmental artery, and the basilar (inferior) segmental artery. These are also referred to as the apical, upper, middle, and lower anterior segmental arteries, respectively. These segmental arteries then divide further into lobar arteries (associated with each renal pyramid) and further into two or three interlobar arteries (Fig. 54–10). The interlobar arteries travel through the renal medulla alongside either side of the pyramids. They divide at the corticomedullary junction into arcuate arteries that give rise to the interlobular arteries that travel radially to the capsule. They give off numerous side branches en route, including the afferent arterioles.
Venous
In parallel to the renal arterial system, the renal venous system progresses from the interlobular veins to the arcuate, interlobar, lobar, and segmental veins (see Fig. 1–32). The segmental veins combine to form three to five venous tributaries, the confluence of which forms the main renal vein near the hilum. Each kidney is typically drained by a single renal vein that courses anterior to the renal artery and joins the lateral aspect of the vena cava. The left renal vein is longer than the right, making the left kidney attractive for donor nephrectomy. The left renal vein typically passes anterior to the aorta.
Unlike the arterial structure of the kidney, the renal venous system is characterized by a rich anastomotic network between the various renal segments. One may ligate and divide segmental veins without compromising drainage. The right renal vein does not receive significant branches. Tributaries draining into the main left renal vein include the gonadal vein, the left adrenal vein, and one or two large lumbar veins, all of which can be injured during mobilization of the left renal vein. Because of these collateral vessels, one is at liberty to ligate the left renal vein at the caval junction without eliminating venous return.
Anomalies of Renal Vasculature
Frequent anatomic variation in the renal vasculature contributes to the complexity of open renal surgery. Multiple renal arteries, which typically arise from the aorta or iliac arteries, are the most common variation, occurring in 25% to 30% of the population (Merklin and Michels, 1958; Boijsen, 1959; April, 1997). Supernumerary hilar renal arteries originate at the aorta adjacent to the renal artery and traverse the renal hilum, whereas polar renal arteries originate at a greater distance from the main renal artery and enter the renal parenchyma directly. Ectopic and horseshoe kidneys more frequently have supernumerary renal arteries (Fig. 54–11).

Figure 54–11 Horseshoe kidney with multiple arterial branches well defined with three-dimensional imaging.
Venous anomalies occur less frequently. Supernumerary renal veins occur less commonly on the left than right (Merklin and Michels, 1958). The most common variation is duplication of a renal vein (6%) (April, 1997). Retroaortic left renal veins occur in approximately 2% of patients. Circumaortic renal veins are present in 1.6% to 6.0% of the population (Kottra and Castellino, 1970). One must be vigilant to identify these infrequent anomalies during preoperative evaluation or intraoperative dissection.
Lymphatics
Lymphatics parallel the arterial system from the renal cortex into the sinus and then empty into hilar nodes associated with the renal vein (see Figs. 1–34 [on the Expert Consult website![]() ] and 1-35). There is communication between parenchymal lymphatics and those of the renal capsule and perinephric fat. From the first description of renal lymphatic drainage in 1935 to modern day lymphatic dissections the complexity of renal lymphatic drainage beyond the hilum has been apparent (Parker, 1935; Assouad et al, 2006). For the surgeon, the most important characteristic of renal lymphatics is variability in drainage. More so than in malignancies of the penis, testis, bladder, and prostate, the role of regional lymphadenectomy in kidney cancer remains controversial.
] and 1-35). There is communication between parenchymal lymphatics and those of the renal capsule and perinephric fat. From the first description of renal lymphatic drainage in 1935 to modern day lymphatic dissections the complexity of renal lymphatic drainage beyond the hilum has been apparent (Parker, 1935; Assouad et al, 2006). For the surgeon, the most important characteristic of renal lymphatics is variability in drainage. More so than in malignancies of the penis, testis, bladder, and prostate, the role of regional lymphadenectomy in kidney cancer remains controversial.
Key Points: Surgical Anatomy
Preoperative Evaluation and Preparation
A thorough preoperative evaluation is essential to safe open renal surgery. The preoperative evaluation is directed at patient selection, staging of disease, identification and optimization of medical comorbidities, imaging, preoperative procedures such as renal artery embolization, and prevention of surgical morbidity. Patient selection and clinical staging of renal disease are covered in other chapters of this text.
Identification and Optimization of Cardiovascular and Pulmonary Comorbidities
Open renal surgery often requires prolonged nonphysiologic positioning with attendant impingement of cardiovascular and pulmonary function. The flank position may impede ventilatory capacity as well as decrease venous return to the heart, with resultant reduction in cardiac output. Patients may have significant bleeding, fluid shifts, or increased oxygen demand, which can result in imbalance in oxygen supply and demand. Preoperative evaluation including laboratory and imaging studies, along with judicious specialist consultation is essential (Table 54–2).
Table 54–2 Preoperative Workup: Basic Components
|
Chest radiograph*
Electrocardiogram*
Pulmonary function testing*
Arterial blood gas analysis*
|
* If deemed necessary after assessment of cardiac and pulmonary risk factors.
Cardiovascular
Some patients will benefit from referral to a consulting cardiologist for consideration of resting 12-lead electrocardiogram, noninvasive evaluation of left ventricular function, noninvasive stress testing, medication adjustments, or preoperative coronary revascularization (coronary artery bypass graft or percutaneous coronary intervention). Patients with unstable coronary syndromes, decompensated heart failure, significant arrhythmias, or severe valvular disease should be evaluated and treated by a cardiologist before noncardiac surgery (Fleisher et al, 2007). It is incumbent on the urologist to identify these patients and others who are at risk of cardiovascular complications and to refer them for evaluation by a specialist.
In addition, patients with known coronary artery disease or signs or symptoms suggestive of new coronary artery disease should receive a preoperative cardiac assessment (Fleisher et al, 2007). In asymptomatic patients, referral should be made based on a history and physical examination (Lee et al, 1999; Fleisher et al, 2007). The history should elucidate symptoms of cardiovascular disease, risk factors for cardiac disease, and pertinent medications (Table 54–3). The Revised Cardiac Risk Index (RCRI), a simple validated index to predict cardiovascular complications, was developed at a tertiary care facility for prediction of cardiac risk of major noncardiac surgery in patients 50 years of age or older (Lee et al, 1999). The RCRI, which is composed of six independent predictors of cardiac complications, identifies patients at risk of cardiac complications (Table 54–4) and may be helpful for preoperative risk stratification.
Table 54–3 Pertinent Cardiovascular History
Table 54–4 Revised Cardiac Risk Index
| Independent Predictors |
| NO. OF RISK FACTORS | RATE OF MAJOR CARDIAC COMPLICATION |
|---|---|
| 0 | 0.4% |
| 1 | 0.9% |
| 2 | 7% |
| 3 or more | 11% |
From Lee TH, Marcantonio ER, Mangione CM, et al. Derivation and prospective validation of a simple index for prediction of cardiac risk of major noncardiac surgery. Circulation 1999;100(10):1043–9.
Pulmonary
In noncardiothoracic surgery, risk factors for postoperative pulmonary complications include chronic obstructive pulmonary disease, age older than 60 years, inhaled tobacco use, American Society of Anesthesiologists (ASA) class II or higher, functional dependence (i.e., inability to perform activities of daily living or need for equipment and assistance for some activities of daily living), congestive heart failure, pulmonary hypertension, and hypoalbuminemia (Qaseem et al, 2006; Bapoje et al, 2007). The urologist should screen for these risk factors and refer the patient for preoperative pulmonary evaluation and risk reduction.
Even in the absence of baseline risk factors, open renal surgery itself may disturb a patient’s pulmonary equilibrium and render him or her at risk for postoperative pulmonary complications. For instance, transection of upper abdominal and flank muscles, removal of ribs, impairment of diaphragm function through nerve or muscular injury, pneumothorax, hemothorax, and pleuritic pain may all contribute to pulmonary difficulties. Prolonged surgery (>3 hours) is an independent predictor of pulmonary complications, as is either thoracic or upper abdominal surgery (Qaseem et al, 2006).
Pulmonology consultation, preoperative pulmonary function testing, chest radiography, or arterial blood gas analysis may benefit patients who are at risk of pulmonary complications. Preoperative interventions such as smoking cessation 6 to 8 weeks before surgery and inspiratory muscle training may reduce the risk of pulmonary complications (Bapoje et al, 2007). In patients with significant pulmonary risk factors or impairment an anterior surgical approach in the supine position might be preferable to the flank approach (Novick, 2007). Risk can be ameliorated after surgery by deep breathing exercises or incentive spirometry and by selective rather than routine use of nasogastric drainage (Qaseem et al, 2006; Bapoje et al, 2007).
Renal Evaluation
Although a definitive discussion of renal impairment and its impact on surgical decision making is beyond the scope of this chapter, assessment of renal function is mandatory before open renal surgery. As discussed later in the section on partial nephrectomy, preservation of renal function is a vitally important aspect of contemporary renal surgery. Knowledge of preoperative renal dysfunction is essential.
Initial renal evaluation should include urinalysis and measurement of serum creatinine concentration. The serum creatinine value is the most widely used surrogate marker of glomerular filtration rate (GFR) but is not ideal. Changes in the serum creatinine level can reflect a change in GFR but may also represent a change in production of creatinine or tubular secretion of creatinine. A better estimate of GFR is provided by 24-hour creatinine clearance (CrCl), which reflects the volume of plasma that is cleared of creatinine per minute. Because creatinine is also cleared by tubular secretion in addition to filtration, the 24-hour CrCl tends to overestimate GFR. GFR can also be estimated by renal radionuclide imaging. For instance, renal scan with technetium-99 diethylenetriaminepentaacetic acid (DTPA) can provide an estimate of GFR but its use is limited in patients with renal insufficiency. A commonly used method, which is favored by the senior author, is to estimate GFR using the Modification of Diet in Renal Disease (MDRD) Study equation (Levey et al, 1999):
If extirpative renal surgery is anticipated to render the patient at high-risk of dialysis dependence, preoperative nephrology referral and placement of hemodialysis access, such as a Tesio catheter (Medical Components, Harleysville, PA), are advisable. Patients must be made aware that the risks of open renal surgery include chronic kidney disease, dialysis dependence, and the systemic consequences of renal insufficiency.
Imaging
Modern imaging permits a thorough anatomic evaluation of the urinary tract before open renal surgery. It is essential to identify anatomic variants before surgery such as supernumerary renal arteries, retroaortic left renal vein, circumaortic renal vein, duplicated collecting system, and renal ectopia. A variety of imaging modalities are available, including intravenous pyelography, retrograde pyelography, ureteroscopy, computed tomography (CT), ultrasonography, magnetic resonance imaging (MRI), renal arteriography, and renal venography.
Three-dimensional (3D) volume-rendered CT is a valuable tool in the evaluation of patients undergoing renal surgery (Coll et al, 1999; Derweesh et al, 2003). CT can demonstrate vital information including the anatomy of the renal vasculature, orientation of the kidney, and characteristics of renal tumors, including location, depth of penetration into the kidney, relationship with collecting system, and segmental arterial supply to the tumor (Coll et al, 1999) (Figs. 54-12 to 54-14). CT is also able to characterize other surgically relevant processes, including renal arterial disease, nephrolithiasis, and hydroureteronephrosis (Herts, 2005).

Figure 54–12 Contrast-enhanced CT axial reconstruction demonstrating large right hypervascular mass suggestive of renal cell carcinoma.

Figure 54–13 CT scan demonstrating two incidentalomas in an elderly man undergoing imaging to rule out appendicitis. A left partial nephrectomy was performed first followed by a right radical nephrectomy in 3 to 4 months.

Figure 54–14 A, Preoperative imaging demonstrates a large 4-cm hilar lesion during a noncontrast film in a patient with a history of von Hippel-Lindau disease. B, Contrast administration demonstrates enhancement of a large intrarenal mass and nearby simple cyst. C, Delayed images depict close proximity to collecting system.
The importance of imaging to open renal surgery is likely to increase with time. Future possibilities include image-guided open surgery, the objective of which is to provide surgeons enhanced visualization of the surgical field by merging data from preoperative images with an intraoperative view (Benincasa et al, 2008). In addition, simulation of complex nephron-sparing surgery based on 3D imaging may be possible (Wunderlich et al, 2000).
Angioembolization
Since its introduction in the early 1970s, renal artery embolization (RAE) has been employed for palliation of inoperable renal tumors, to control bleeding, and as part of multimodal treatment of hypervascular metastatic disease (Almgard et al, 1973). In addition, RAE is used as a preoperative adjunct to resection of locally advanced renal tumors, with or without metastases (Paster et al, 1975) (Fig. 54–15).

Figure 54–15 A, Aortogram in a patient with a left hypervascular renal mass. Note the pooling of contrast medium in the upper pole. B, Left selective artery angiogram before coil placement. C, Aortogram after coil placement demonstrating abrupt cutoff of flow from the left renal artery.
Proposed benefits of preoperative RAE include shrinkage of an arterialized tumor thrombus to ease surgical removal, reduced blood loss, facilitation of dissection due to tissue plane edema, ability to ligate the renal vein before the renal artery at time of nephrectomy, and modulation of the immune response (Klimberg et al, 1985; Bakal et al, 1993; Kalman and Varenhorst, 1999; Schwartz et al, 2007; Wotkowicz and Libertino, 2007; Wszolek et al, 2008). Ligation of the renal vein before the renal artery is useful in the setting of hilar tumors, tumors with significant medial extension, or considerable perihilar adenopathy (Schwartz et al, 2007; Wotkowicz and Libertino, 2007; Wszolek et al, 2008). Before ligating the renal vein, one should characterize the completeness of embolization to prevent unnecessary blood loss in cases of incomplete embolization. In the senior author’s experience this assessment can be made by evaluating renal venous return during surgery. In addition, angioembolization can also be useful for renal tumors associated with large arteriovenous malformations that are having a deleterious hemodynamic impact (Figs. 54-16 and 54-17).

Figure 54–16 Noncontrast (A) and contrast-enhanced (B) CT images of a patient with high output cardiac failure secondary to arteriovenous malformation associated with left renal cell carcinoma. Notice the equal contrast intensity of the aorta, left renal artery, and left renal vein.

Figure 54–17 A, Left selective renal angiogram demonstrates immediate filling of the renal vein and inferior vena cava. B, Angiogram after placement of coils demonstrates complete angioinfarction. Contrast medium in the contralateral renal pelvis confirms contralateral renal function.
There may be a survival benefit to preoperative RAE. In a case-control study, preoperative RAE and nephrectomy was associated with a survival benefit when compared with nephrectomy alone (Zielinski et al, 2000). In comparison to matched controls, preoperative RAE was associated with improved overall survival at 5 years (62% vs. 35%, P = .01) and 10 years (47% vs. 23%, P = .01). This possible survival benefit has not been demonstrated in a prospective trial.
Although there is no conclusive evidence that RAE has any immunotherapeutic benefit it is plausible that angioinfarction may augment the immune response to the renal tumor (Kalman and Varenhorst, 1999). There are reports of regression of metastases from renal cell carcinoma after RAE and nephrectomy (Mohr and Whitesel, 1979; Swanson et al, 1983). The postinfarction syndrome that is nearly universal may be cytokine mediated. Several studies have shown that RAE is immunomodulatory, with documented changes in natural killer cell activity (Bakke et al, 1982), increased cell-mediated cytotoxicity (Johnson and Kalland, 1984), and alteration in lymphocyte proliferation (Nakano et al, 1983). There are no modern molecular data to support these findings.
The postinfarction syndrome, which is characterized by flank pain, nausea, and fever, occurs in approximately three fourths of patients and is the most frequently cited complication of RAE (Schwartz et al, 2007). Other complications, including incomplete embolization, coil migration, and groin hematoma, occurred in fewer than 5% of patients (Schwartz et al, 2007). Rarely cited complications include hyponatremia (Huang et al, 2003), paraplegia due to occlusion of spinal arteries, or inadvertent angioinfarction of other organs such as the colon (Roy et al, 1999).
The data regarding preoperative RAE are limited, without any randomized trials evaluating the technique. As a result, in some institutions, surgeons rarely employ preoperative RAE (Boorjian et al, 2007). It is the practice of the senior author to perform preoperative RAE for large renal tumors with hypervascular characteristics or IVC tumor thrombus (Wotkowicz and Libertino, 2007). The ideal timing of nephrectomy after embolization is unclear (Craven et al, 1991; Weckermann et al, 1992; Kalman and Varenhorst, 1999; Schwartz et al, 2007). At the Lahey Clinic, surgery usually is timed 4 weeks after angioinfarction. An imaging study to assess the cranial limit of tumor thrombus is repeated shortly before the operation. Although prospective trials are needed to evaluate the role of preoperative RAE in the treatment of renal cell carcinoma, the senior author has found it a useful preoperative adjunct in the management of locally advanced RCC.
Surgical Site Infection Prophylaxis
A preoperative urinalysis and culture should be obtained for all patients undergoing open renal surgery. Patients with urinary tract infection or bacteriuria should be treated with culture-guided antibiotics before surgery, with the goal of sterilizing the urine or reducing the bacterial count if the urine cannot be sterilized (Wolf et al, 2008).
In the absence of active infection or bacteriuria, judicious antimicrobial prophylaxis may reduce the risk of surgical site infection and systemic sepsis. In cases in which the urinary tract is not entered, such as radical nephrectomy, antibiotics should be targeted to skin flora (e.g., a first-generation cephalosporin or clindamycin). The American Urological Association (AUA) advises that in these clean cases the use of antibiotics should be limited to patients with risk factors (Table 54–5) (Wolf et al, 2008). In renal surgery in which the urinary tract is entered both skin and genitourinary flora should be covered (with a first- or second-generation cephalosporin or aminoglycoside with metronidazole or clindamycin, or ampicillin/sulbactam, or fluoroquinolone) (Wolf et al, 2008).
Table 54–5 Risk Factors for Surgical Site Infection
| Alteration in Host Defense |
| Alteration in Pathogen |
From Wolf JS Jr, Bennett CJ, Dmochowski RR, et al. Best practice policy statement on urologic surgery antimicrobial prophylaxis. J Urol 2008;179(4):1379–90.
Open renal surgery is often complex and time consuming. Antibiotics should be readministered during surgery after one to two half-lives to ensure adequate drug levels are maintained until wound closure (Bratzler and Houck, 2005). Antibiotic prophylaxis should not continue beyond 24 hours (Bratzler and Houck, 2005).
In addition to antibiotics, sterile technique is employed to reduce the rate of surgical site infection. Although there is no conclusive evidence to support hair removal as a method of reducing surgical site infection, the authors recommend clipping hair at the incision site before sterile preparation of the field (Tanner et al, 2006). It is the practice of the senior author to use povidone-iodine scrub and paint, although one study has found paint alone to be equivalent to scrub and paint for abdominal surgery (Ellenhorn et al, 2005). One should avoid alcohol-containing products because of flammability (Armstrong et al, 2001). Finally, proper surgical technique with regard to tissue handling, hemostasis, avoidance of unnecessary hypothermia, and excision of devitalized tissues is an essential component of infection prevention (Mangram et al, 1999).
Venous Thromboembolism Prophylaxis
There is a paucity of date to guide prophylaxis for venous thromboembolism (VTE) in open renal surgery. Although both the AUA and American College of Chest Physicians (ACCP) guidelines recommend pharmacologic VTE prophylaxis in open renal surgery, the data supporting these recommendations are imperfect (Geerts et al, 2008; Forrest et al, 2009). The ACCP recommends routine VTE prophylaxis in all open urologic procedures, although this recommendation is largely based on data from other surgical specialties and radical retropubic prostatectomy. The ACCP recommends preoperative use of graduated compression stockings along with intermittent pneumatic compression devices, pharmacologic prophylaxis after surgery (low-dose unfractionated heparin, low-molecular-weight heparin, or fondaparinux), or both. In patients at high risk of bleeding, the ACCP advises pharmacologic therapy once the bleeding risk has diminished. The AUA recommends use of mechanical prophylaxis in all patients undergoing open surgery and consideration of pharmacologic prophylaxis in patients with elevated risk for VTE (Tables 54-6 and 54-7).
Table 54–6 Venous Thromboembolism: Risk Stratification
| Low Risk |
| Minor surgery in patients younger than age 40 years with no additional risk factors |
| Moderate Risk |
| High Risk |
| Highest Risk |
| Surgery in patients with multiple risk factors |
Data from Geerts and colleagues (2008) and Forrest and colleagues (2009).
Table 54–7 Venous Thromboembolism: Risk Factors
Data from Geerts and colleagues (2008) and Forrest and colleagues (2009).
It is the authors’ practice to apply intermittent pneumatic compression devices before open renal surgery for all patients. In the opinion of the senior author there is not sufficient evidence to support routine use of pharmacologic VTE prophylaxis given the associated risk of hemorrhage. At the Lahey Clinic addition of pharmacologic prophylaxis is determined on a case-by-case basis by subjectively assessing an individual’s risk of VTE (see Tables 54-6 and 54-7). In partial nephrectomy, a procedure with significant risk of hemorrhage, pharmacologic prophylaxis is avoided in the vast majority of cases at the Lahey Clinic. This practice is supported by a retrospective review from Memorial Sloan-Kettering Cancer Center that describes a low prevalence (1.5%) of clinically apparent VTE after radical or partial nephrectomy (Pettus et al, 2006). This is an order of magnitude lower than the estimated 15% to 40% rate of asymptomatic VTE (i.e., found on screening) on which the current ACCP recommendations are based (Geerts et al, 2008). The clinical significance of asymptomatic VTE is unclear.
Key Points: Preoperative Evaluation and Preparation
Surgical Approaches
Safe, effective open renal surgery is predicated on good functional exposure of the kidney. The kidney is a retroperitoneal structure in close proximity to the great vessels, pancreas, spleen, liver, colon, and duodenum. These neighbors serve as landmarks to guide dissection, as well as potential sources of complications and impediment to adequate exposure. An incision that is too small or inappropriately placed will increase the difficulty of open renal surgery and may adversely impact patient outcomes. Good functional exposure permits the surgeon to perform the planned procedure, diminishes the risk of injury to surrounding structures, and permits definitive treatment of an intraoperative complication, such as injury to a great vessel (Libertino, 1998). Proper exposure limits the amount of required retraction, which can be a source of injury to surrounding structures such as the liver or spleen (Cooper et al, 1996).
One must balance numerous variables when selecting a surgical approach to the kidney. The ideal surgical approach is one that is tailored not only to the operation being performed but also to the anatomy as defined on preoperative imaging, previous surgical history, body habitus, and presence of limiting factors such as kyphoscoliosis or pulmonary disease (Libertino, 1998).
The primary approaches to the kidney are the subcostal, supracostal, and transcostal flank incisions, the thoracoabdominal approach, the dorsal lumbotomy, as well as the midline, paramedian, and subcostal anterior approaches (Table 54–8).
Flank Approaches
The flank approaches are undertaken with the patient in lateral decubitus position with flexion of the table. Flexion tightens the skin and muscles of the flank and improves exposure by increasing the distance between the iliac crest and costal margin. Positioning for the flank approaches can impede pulmonary function and venous return to the heart, with resultant deficits in ventilation and cardiac output (Longnecker, 2007). When the table is flexed with the kidney bar elevated, ischemic injury to a previously operated on contralateral kidney may result (Matin and Novick, 2001). Flank approaches may not be ideal in patients with preexisting cardiopulmonary deficits or kyphoscoliosis. Each of the flank approaches can result in injury to the intercostal nerves with denervation and paresis of the flank musculature, leading to chronic postoperative pain or flank bulge in 3% to 49% of patients (Ward et al, 1974; Chatterjee et al, 2004). Gravity will tend to move the abdominal panniculus of an obese patient away from the operative field, a distinct advantage of the flank approaches.
It is imperative to understand the anatomy of the flank before employing these approaches (see Figs. 1–3, 1–4, 1–5, and 1–8). There are three principal flank approaches: subcostal, supracostal, and through the bed of a resected rib.
Subcostal Flank Approach
This approach offers good exposure of the renal parenchyma and upper ureter. It is an advantageous approach for surgery on the lower renal pole, UPJ, and upper ureter (e.g., ureterocalicostomy, pyeloplasty, and stone surgery). Simple nephrectomy, insertion of a nephrostomy tube, and drainage of a perinephric abscess may all be accomplished through a subcostal flank incision. Because the approach is extraperitoneal, contamination of the peritoneal cavity is avoided. Access to the renal hilum and vascular pedicle is poor, which is the most salient disadvantage of this approach. The subcostal flank approach is not appropriate for radical or partial nephrectomy (Libertino, 1998). The incision may be caudal to the kidney, hampering access to the upper pole, renal pelvis, and hilum (Novick, 2007). Exposure may be further hindered by the iliac crest and subcostal nerve, the anterior division of the 12th thoracic nerve.
After induction of anesthesia, insertion of an endotracheal tube, and introduction of a Foley catheter into the urinary bladder to monitor urine output, the patient is placed in the lateral position. The head is supported to maintain proper alignment of the cervical spine. The tip of the 12th rib should be positioned over the kidney bar (Fig. 54–18). The patient’s back should be nearly flush with the edge of the table to ensure unfettered access by the surgeon. To preserve stability and prevent forward roll, the dependent leg is flexed at the hip and knee and the top leg is kept straight. A pillow is placed between the knees. An axillary roll is deployed just caudal to the axilla to prevent compression or injury of the axillary neurovascular bundle. Other pressure points, including the upper foot, are padded with foam. The nondependent arm should be placed on a padded Mayo stand so that the arm is horizontal with slight forward rotation at the shoulder. The bed is flexed until the flank muscles are under stretch. A kidney bar can be employed if necessary. The bed is placed in Trendelenburg position so that the flank is rendered parallel to the floor. The patient is secured to the mobile part of operating table with 2-inch wide adhesive tape, which fixes the patient in place while allowing adjustment of flexion.

Figure 54–18 Position of the patient for the flank approach. Note the axillary pad. The kidney rest may be elevated if further lateral extension is needed.
After sterile preparation and draping, the skin incision begins at the costovertebral angle, approximately at the lateral border of the sacrospinalis muscle just inferior to the 12th rib. The incision is made a fingerbreadth below and parallel to the 12th rib and is carried onto the anterior abdominal wall. In an attempt to avoid the subcostal nerve, the incision can be curved gently downward at the midaxillary line. If needed, the incision can be extended caudally or medially to the lateral border of the rectus abdominis.
The incision is carried sharply through the subcutaneous tissue, exposing the fascia of the latissimus dorsi and external oblique muscles (Fig. 54–19). Electrocautery is used to incise the muscles in the line of the incision (Fig. 54–20), starting with the latissimus dorsi posteriorly. The serratus posterior inferior muscles, which insert into the lower four ribs, are also encountered in the posterior portion of the wound and transected. In the anterior aspect of the wound the external oblique muscle is divided. These maneuvers expose the fused lumbodorsal fascia, which gives rise to the internal oblique and transversus abdominis muscles. The lumbodorsal fascia and internal oblique muscle are divided (Fig. 54–21). By using two fingers inserted into an opening created in the lumbodorsal fascia at the tip of the 12th rib, the peritoneum is swept medially as the transversus abdominis is split digitally. The subcostal nerve should be identified between the internal oblique and transversus abdominis muscles and spared (Figs. 54-22 and 54-23).

Figure 54–19 Superficial incision through flank.
(From Libertino JA. Reconstructive urologic surgery. 3rd ed. Philadelphia: Mosby; 1997.)

Figure 54–20 Left subcostal incision. The latissimus dorsi muscle has been divided to expose the lumbodorsal fascia and the posterior aspects of the abdominal muscles.

Figure 54–21 Dissection through flank muscles.
(From Libertino JA. Reconstructive urologic surgery. 3rd ed. Philadelphia: Mosby; 1997.)

Figure 54–22 Opening lumbodorsal fascia to gain entrance to retroperitoneum.
(From Libertino JA. Reconstructive urologic surgery. 3rd ed. Philadelphia: Mosby; 1997.)

Figure 54–23 The lumbodorsal fascia and transverse muscles have been divided to expose the Gerota fascia. The subcostal nerve and vessels pierce the lumbodorsal fascia posteriorly and course forward on the transverse muscle.
To maximize exposure in the posterior aspect of the incision, one may incise the posterior angle of the lumbodorsal fascia, exposing the sacrospinalis and quadratus lumborum muscles. Dividing the costovertebral ligament permits superior retraction of the 12th rib if enhanced exposure is deemed necessary. A Bookwalter (Codman & Shurtleff, Raynham, MA) flank retractor is used for exposure.
To facilitate wound closure, the kidney bar is lowered and the table is partially taken out of flexion. The wound is closed in layers using No. 2 Nylon. The transversus abdominis and internal oblique muscles are closed in one layer. The lumbodorsal fascia is reapproximated, followed by the external oblique, serratus posterior inferior, and latissimus dorsi muscles. The skin edges are reapproximated with staples or subcuticular 2-0 polyglactin (Vicryl). A closed drainage system or Penrose drain should be externalized through a small counterincision below the wound. After applying a sterile dressing to the wound, the authors place the Penrose drain into a collection bag designed for urinary stomas, which is secured to the abdominal wall. This allows drainage to be easily recorded and protects the skin from the drain output.
Supracostal Flank Approach
The supracostal flank incision is favored at the Lahey Clinic for most modest-sized renal tumors and most partial nephrectomies (Fig. 54–24). When properly executed it affords an extraperitoneal, extrapleural approach to the kidney with excellent exposure of the renal and suprarenal areas. In addition, this approach permits the 11th or 12th rib to pivot posteriorly without removing a rib. Turner-Warwick (1965), who popularized the approach, believed that the supracostal approach provides maximal posterior exposure, simplifies wound closure, and is less morbid than a transcostal incision requiring rib resection. More recently, an 8-cm modified mini-flank supra-11th rib incision has been described as a safe, effective approach to radical or partial nephrectomy for renal cortical tumors (Diblasio et al, 2006).
The level of the incision is determined by the patient’s anatomy, location of the lesion, and the operation planned. For partial nephrectomy the level of incision is determined by the position of the kidney in relation to the ribs as seen on preoperative radiographic studies and by the location and size of the tumor.
The patient is positioned as described for the subcostal flank incision. A skin incision at the superior aspect of the 12th or 11th rib is made, beginning at the lateral border of the sacrospinalis muscle and continuing until the lateral border of the ipsilateral rectus abdominis muscle. The incision is carried sharply through the subcutaneous tissue. The latissimus dorsi and serratus posterior inferior muscles are transected in the posterior aspect of the wound, revealing the intercostal muscles.
The external and internal oblique muscles are divided. The lumbodorsal fascia is opened at the tip of the rib to avoid both peritoneum and pleura. Moving medially, the transversus abdominis muscle is divided carefully while sweeping the peritoneum medially and inferiorly. The diaphragm is exposed by transection of the transversalis muscle. The pleura is identified between the divided transverses abdominis muscle and the diaphragm and can be mobilized superiorly.
The lateral aspect of the sacrospinalis is identified and is either incised or retracted to permit access to the neck of the rib and its attachments. Division of the intercostal muscles should start at the most distal aspect of the rib and proceed toward the spine. The corresponding intercostal nerve is identified and spared. To avoid the neurovascular bundle the intercostal muscles are divided in close proximity to the superior aspect of the rib. The plane between the chest wall and pleura is developed by entering the investing fascia surrounding the intercostal nerve, which allows an extrapleural dissection (Fig. 54–25). The slips of the diaphragm attached to the inferior ribs are transected. Proceeding posteriorly, the intercostal or transverse costal ligament is divided, which permits free movement of the 12th rib (supra 12th) or the 11th and 12th rib (supra 11th).

Figure 54–25 Following the intercostal nerve to remain extrapleural back to the intercostal ligament.
(© The Lahey Clinic.)
Proper closure restores separation between the thoracic and abdominal cavities. At time of closure, local anesthetic can be used to perform an intercostal nerve block under direct vision. As described by Turner-Warwick (1965), the detached diaphragm is externalized through the intercostal space and sutured to the free edge of the intercostal muscles and to the inferior cut edge of the serratus posterior inferior muscle. The edges of the transected latissimus dorsi muscle are reapproximated while incorporating the upper margin of the serratus posterior inferior muscle. A drain is externalized through a separate stab incision.
Over time, the senior author has modified the closure of the supracostal incision. The diaphragm is closed primarily and not externalized. A rib punch is used to create a hole in the rib above and below the incision. A No. 2 Nylon suture, which is passed through the ribs and the diaphragm, is used to restore integrity of the chest wall. The latissimus dorsi, serratus posterior inferior, and intercostal muscles are closed in a single layer.
Transcostal Flank Approach
The classic flank approach involves resection of the 11th or 12th rib and entrance into the retroperitoneum through the bed of the resected rib (Hess, 1939; Hughes, 1949; Bodner and Briskin, 1950). It provides similar exposure to the supracostal incision but is a more complicated and more morbid incision. This transcostal approach fell out of favor at the Lahey Clinic decades ago with the advent of the supracostal approach.
The site of incision is determined by the position of the kidney and the location of disease. Typically, for a lower pole tumor a supra-12th rib incision is adequate. For mid and upper pole tumors, a supra-11th incision is often satisfactory. On a urogram a horizontal line that traverses the hilum of the kidney will intersect with the rib that should be resected. In cases requiring upper pole access the surgeon should approach the kidney through the rib above the one indicated by the horizontal line transversing the hilum.
The patient is placed in the flank position. A trans-12th rib approach will be described. The skin is incised directly over the 12th rib from the lateral border of the sacrospinalis muscle and continuing until the lateral border of the ipsilateral rectus abdominis muscle. The latissimus dorsi, serratus posterior inferior, and external oblique muscles are divided with electrocautery over the center of the 12th rib, exposing the periosteum. The periosteum is incised with a knife. A periosteal elevator is employed to separate the rib from its periosteum. One must be vigilant to preserve the neurovascular bundle.
The exposed rib is resected with a rib cutter as posterior as possible. Rongeurs help remove additional rib and sharp fragments. Bone wax is used to obtain hemostasis and a smooth surface. The anterior attachments of the rib are divided, permitting the rib to be excised.
One enters the retroperitoneum by incising the posterior layer of periosteum at the tip of the rib. As the incision is extended laterally along the length of the rib bed, a finger is used to sweep away the pleura and peritoneum. The internal oblique is divided with cautery. Proceeding anteriorly, the transversus abdominis is then split with fingers. As in other flank approaches, effort should be made to preserve the 12th nerve coursing between the internal oblique and transverse muscles. The pleura is sharply separated from the fascia under the 11th rib above. The diaphragmatic attachments to the thoracoabdominal wall are divided. With sharp dissection the peritoneum is released from the transverse fascia to improve exposure.
In cases of 11th rib resection, the pleural reflection will be in the posterior aspect of the wound atop the diaphragm. One can mobilize the pleura superiorly by dividing its attachments to the diaphragm, or the two can be mobilized together by dividing the diaphragm.
To close the wound, the kidney rest is lowered and flexion is partially reduced. The incision is closed in layers. If an inadvertent pleural tear was created, an 8-Fr “dart” chest drain (Arrow International, Reading, PA) is placed and the pleural defect is closed using 2-0 silk. Infiltration of local anesthetic into the fascia around the intercostal nerves is helpful for analgesia. Drains are brought out through a separate stab incision.
Thoracoabdominal Approach
The thoracoabdominal approach (Fig. 54–26) is used for the management of large renal masses, suprarenal or upper pole masses, renal tumors with venous extension, as well as tumors involving adjacent structures (Mortensen, 1948; Chute et al, 1949; Cooper et al, 2002). The incision provides maximal suprarenal exposure. It is particularly useful on the right side, where the liver and hepatic veins impede exposure and make control of the renal pedicle difficult. This transpleural incision may be associated with additional pulmonary morbidity compared with the other flank or anterior approaches (Novick, 2007), but the incision permits resection of very large tumors, including those that involve adjacent structures (Buse et al, 2006). The phrenic nerve may be injured in this approach, compromising diaphragmatic function.

Figure 54–26 Thoracoabdominal incision at the supra-tenth border with patient in lateral decubitus position.
For this approach the flank position is modified to permit access to the anterior abdominal wall. The patient is positioned in a semi-oblique manner with a rolled blanket or beanbag supporting the flank. The legs are positioned similar to the traditional flank position. The pelvis is rotated in a more horizontal position than in the flank incisions, at an angle of approximately 75 degrees rather than 90 degrees from level.
The level of the incision is determined by the nature of the tumor, including size and relationship to surrounding structures such as the liver. In the experience of the senior author, approaching through the 9th or 10th interspace provides sufficient exposure in the majority of cases. For particularly large tumors or those involving the liver, an incision through the 8th interspace may be required. Dividing the intercostal ligament is an essential maneuver to obtain good exposure.
The skin incision begins at the lateral aspect of the sacrospinalis muscle over the 10th or 11th rib and travels obliquely across the anterior abdominal wall to the midpoint of the contralateral rectus abdominis muscle above the umbilicus. Alternatively, the incision can be carried caudally toward the symphysis pubis. The subcutaneous tissues are divided with cautery.
In patients with involvement of the IVC the abdominal portion of the wound should be opened first to permit exploration for evidence of metastatic disease. Otherwise, the chest and abdomen can be opened in the order of preference of the surgeon. The rectus abdominis, external oblique, latissimus dorsi, and serratus inferior posterior muscles are divided. The internal oblique and transversus abdominis muscles are transected. The underlying peritoneum is opened, and the peritoneal cavity is explored.
The chest is entered. The costal cartilage is transected. While staying close to the superior border of the rib, the intercostal muscles are divided. This exposes the underlying pleura and diaphragm. The pleura is opened sharply, taking care to avoid the lung. The costovertebral ligament is divided. The diaphragm is opened from its thoracic surface. Starting anteriorly and proceeding posteriorly, the diaphragm is opened in a curvilinear fashion staying about two fingerbreadths from the chest wall to avoid injuring the more central phrenic nerve.
The liver or spleen is gently retracted upward. Additional hepatic mobility can be obtained by dividing the coronary ligament and the right triangular ligament of the liver (Figs. 54-27 and 54-28). For right-sided tumors, the kidney and great vessels are approached by mobilizing the colon medially and kocherizing the duodenum (Fig. 54–29). For tumors on the left, the colon and the tail of the pancreas are mobilized, providing excellent exposure of the renal pedicle.

Figure 54–27 Relationship of liver and triangular and coronary ligaments to vena cava. IVC, inferior vena cava.
(© The Lahey Clinic.)

Figure 54–28 Posterior view of relationship of liver and triangular and coronary ligaments to vena cava. IVC, inferior vena cava; Ao, aorta.
(© The Lahey Clinic.)
After the procedure the posterior peritoneum is closed with running 2-0 polyglactin. The continuity of the diaphragm is restored with 2-0 silk, with the knots tied on the abdominal surface. When necessary the diaphragm can be repaired with a polytetrafluoroethylene (PTFE) patch (W. L. Gore and Associates, Medical Products Division, Flagstaff, AZ). The integrity of the rib cage is restored by reapproximating the costal arch with No. 2 Nylon. An 8-Fr “dart” chest drain is placed and attached to a Pleur-Evac drainage system (Teleflex, Research Triangle Park, NC). The pleura and intercostal muscles are reapproximated using 2-0 polyglactin, taking care to incorporate the diaphragm toward the medial surface. The anterior peritoneum is closed with 2-0 polyglactin. The abdominal wall muscles and rectus sheaths are reapproximated with 1-0 polydioxanone (PDS). The subcutaneous tissue is brought together with 3-0 plain suture. Staples are used to close the skin. A Penrose drain is externalized through a separate stab incision.
Dorsal Lumbotomy
The lumbodorsal approach is useful for simple nephrectomy for a small atrophic kidney, simultaneous bilateral simple nephrectomies, renal biopsy, pyeloplasty, pyelolithotomy and upper ureterolithotomy, and other procedures on the renal pelvis or upper ureter (Andaloro and Lilien, 1975; Gardiner et al, 1979; Novick, 1980) (see Figs. 54-30 and 54-31 on the Expert Consult website![]() ). The incision is particularly advantageous in patients with extensive prior abdominal or flank operations because it avoids dissection in scarred or adhesed planes. Because muscles are retracted rather than transected, patients benefit from less pain and a strong closure (Gil-Vernet, 1964; Gardiner et al, 1979). Postoperative flank bulges are less common than with the flank approaches. Rib resection is not necessary because exposure is adequate with division of the costovertebral ligament and rib retraction (Gardiner et al, 1979; Novick, 2007). The lumbodorsal approach is appropriate neither for large kidneys nor for those that are superiorly displaced. The incision provides limited exposure of the ureter and is thus not ideal for operations requiring dissection beyond the upper ureter. The lumbodorsal approach allows marginal access to the renal hilum that may adversely impact control of the renal vasculature. This is the most significant shortcoming of the approach.
). The incision is particularly advantageous in patients with extensive prior abdominal or flank operations because it avoids dissection in scarred or adhesed planes. Because muscles are retracted rather than transected, patients benefit from less pain and a strong closure (Gil-Vernet, 1964; Gardiner et al, 1979). Postoperative flank bulges are less common than with the flank approaches. Rib resection is not necessary because exposure is adequate with division of the costovertebral ligament and rib retraction (Gardiner et al, 1979; Novick, 2007). The lumbodorsal approach is appropriate neither for large kidneys nor for those that are superiorly displaced. The incision provides limited exposure of the ureter and is thus not ideal for operations requiring dissection beyond the upper ureter. The lumbodorsal approach allows marginal access to the renal hilum that may adversely impact control of the renal vasculature. This is the most significant shortcoming of the approach.

Figure 54–30 Posterior exposure and rotation of pelvis providing access for pyeloplasty repair. Proximal ureter (yellow vessel loop). Patient had extensive prior abdominal explorations and bowel resections for inflammatory bowel disease.

Figure 54–31 Renal pelvis exposed and ureter is spatulated before anastomosis with pelvis. Stay sutures are preplaced with 3-0 polyglactin.
For a unilateral procedure the patient is placed in the lateral decubitus position with the table minimally flexed (Fig. 54–32). In the case of a bilateral procedure the patient is placed prone with the table partially flexed to broaden the distance between the iliac crest and 12th rib (Fig. 54–33). Supports under the sternum and pubis permit movement of the anterior abdominal wall with respiration.
The dorsal lumbotomy is an anatomic approach to the kidney, with incision of fascial planes rather than muscle (see Fig. 54–3). A vertical skin incision is made from the inferior border of the 12th rib to the iliac crest, in line with the lateral border of the sacrospinalis muscle. The subcutaneous tissues are divided, exposing the latissimus dorsi muscle. The aponeurosis of the latissimus dorsi is separated from the posterior layer of the lumbodorsal fascia where it overlies the sacrospinalis muscle. The posterior layer of the lumbodorsal fascia, a strong fascial covering, is incised, which allows the sacrospinalis muscle to be retracted medially. The costovertebral ligament is divided, which permits superolateral retraction of the 12th rib, which improves access superiorly. The fused middle and anterior layers of the lumbodorsal fascia are divided, permitting the quadratus lumborum muscle to be retracted medially (Fig. 54–34). The ilioinguinal nerve should be identified and spared. Entry into the paranephric space is achieved by incising the transversalis fascia. Division of the perinephric fascia reveals the kidney.

Figure 54–34 Cross-sectional view of Gil-Vernet approach.
(From Libertino JA. Reconstructive urologic surgery. 3rd ed. Philadelphia: Mosby; 1997.)
The incision is closed by returning the muscles to anatomic position and by reapproximating the lumbodorsal fascia. Some advocate closure of the lumbodorsal fascia in two layers, although reapproximation of the fascia overlying the sacrospinalis muscle as a single layer may be adequate (Menon, 1998). A drain should be externalized.
Anterior Approaches
The anterior incisions can be used for either transperitoneal or extraperitoneal access to the kidney (Fig. 54–35). The transperitoneal anterior approaches offer good access to the renal pedicle at the expense of a longer postoperative ileus and risk of future small bowel obstruction due to intra-abdominal adhesions. Seprafilm (Genzyme Corporation, Cambridge, MA), a sodium hyaluronate and carboxymethylcellulose membrane, can be used to decrease the risk of adhesions. The extraperitoneal anterior approaches provide inferior exposure and are of limited utility.
Anterior Midline
An anterior midline incision is the incision of choice for management of renal trauma because it permits exploration for associated intraperitoneal injuries. It can also be employed for renovascular surgery, reconstructive procedures including ileal ureteral replacement, and bilateral renal procedures.
With the patient in the supine position, a midline skin incision is made from the xiphoid process to the symphysis pubis, curving around the umbilicus. After dividing the subcutaneous tissues with electrocautery, the linea alba is sharply incised to expose the underlying preperitoneal fat and peritoneum. The peritoneum is grasped with two smooth forceps and elevated to reduce risk of bowel injury. The peritoneum is sharply opened between the two forceps. A finger is inserted into the peritoneal cavity and is used to tent the peritoneum away from bowel as the incision is extended with scissors. The ligamentum teres should be divided and suture ligated.
Control of the renal pedicle can be obtained directly through the posterior parietal peritoneum or by medial reflection of the colon. On the left, the approach involves a vertical incision in the posterior peritoneum below the ligament of Treitz. This space contains the anterior surface of the aorta, the crossing left renal vein, and often the inferior mesenteric vein and gonadal vessels. The superior mesenteric artery should be on the anterior surface of the aorta and is usually 1 to 2 cm cephalad to the left renal vein. Gentle dissection along the hilum at this level provides good vascular control. A second approach to the left renal hilum is through the lesser sac. In this approach, the gastrocolic omentum is divided and entered. The transverse colon can then be retracted inferiorly. The peritoneum below the pancreas can be incised. The vessels are identified (Fig. 54–36). It is the authors’ preference to incise the colon along the white line of Toldt and reflect the colon anteromedially. This permits access to the renal pedicle both anteriorly and posteriorly. The artery can be isolated posteriorly and the venous system identified and controlled anteriorly.

Figure 54–36 A, Left gastrocolic, phrenocolic, and lateral peritoneal attachments are divided. B, Stomach, pancreas, and spleen are gently retracted upward without mobilizing kidney.
(© The Lahey Clinic.)
Similarly, the right kidney can be reached directly by incision of the hepatic flexure and a Kocher maneuver to free the duodenum and reflect it medially. Further incision along the white line of Toldt frees the colon, permitting exposure of the anterior Gerota fascia. After the duodenum is reflected, the anterior surface of the vena cava is exposed. Care is taken not to injure the pancreas, gonadal vein, adrenal vein, or accessory renal vessels. The main renal vein is mobilized. Posterior to the renal vein along its superior margin lies the renal artery (Fig. 54–37), which normally runs a retrocaval course. The renal artery can be isolated here or between the vena cava and aorta when greater length is required.

Figure 54–37 Exposure of right renal artery behind overlying left renal vein. IVC, inferior vena cava; Ao, aorta.
(© The Lahey Clinic.)
After the procedure is complete, the peritoneum is closed with 2-0 polyglactin. The fascia is closed with polypropylene (Prolene) or polydioxanone. After bringing the subcutaneous tissues together with 3-0 plain sutures, the skin edges are reapproximated with staples or subcuticular 2-0 polyglactin. A Penrose drain is externalized through a separate stab incision.
Anterior Paramedian
The paramedian approach, which is a straightforward incision with a strong closure, is occasionally employed but provides limited exposure to the kidney. A paramedian skin incision is made approximately 3 cm lateral to the midline. The subcutaneous tissues are divided with electrocautery. The anterior rectus sheath is divided. By sharply transecting the transverse tendinous intersections, one is able to reflect the belly of the muscle medially. The posterior rectus sheath and transversalis fascia are then divided in the line of the incision.
By developing the plane between the peritoneum and transversalis fascia from diaphragm to iliac crest, one can make an extraperitoneal approach to the kidney, although this offers marginal renal access (Tessler et al, 1975). Alternatively, the peritoneum is opened and the kidney is approached as described earlier.
The peritoneum is closed with 2-0 polyglactin. The fascia is closed with polypropylene or polydioxanone. After bringing the subcutaneous tissues together with 3-0 plain sutures, the skin edges are reapproximated with staples or subcuticular 2-0 polyglactin. A Penrose drain is externalized through a separate stab incision.
Anterior Subcostal
The transperitoneal anterior subcostal incision can be employed for both radical and partial nephrectomy, especially for upper pole tumors. With extension of the incision to the lateral border of the contralateral rectus abdominis muscle, the transperitoneal anterior subcostal approach can be used for renovascular surgery. The extraperitoneal subcostal incision has limited utility in adults owing to marginal access to the renal pedicle. It is rarely employed.
The patient is placed in the supine position. The skin is incised from the tip of the 11th rib to the contralateral rectus abdominis muscle, starting two fingerbreadths below the costal margin. The subcutaneous tissues are divided with electrocautery, exposing the external oblique muscle laterally and the rectus sheath medially. After dividing fibers of the latissimus dorsi muscle in the lateral aspect of the wound, the external oblique muscle is transected. The anterior rectus sheath is opened, and the rectus abdominis muscle is retracted medially or divided. The internal oblique muscle, transversus abdominis muscle, posterior layer of the rectus sheath, and the transversalis fascia are divided. This exposes the underlying peritoneum.
For the extraperitoneal approach the peritoneum is reflected from the transversalis fascia using blunt dissection. The retroperitoneal space is entered laterally while retracting the peritoneum and its contents medially. In the more commonly employed transperitoneal approach the peritoneum is opened. The ligamentum teres is encountered in the midline, divided, and suture ligated. The kidneys are approached as described earlier.
The peritoneum is closed with 2-0 polyglactin. The fascia is closed with 1-0 polydioxanone. After bringing the subcutaneous tissues together with 3-0 plain sutures, the skin edges are reapproximated with staples or subcuticular 2-0 polyglactin. A Penrose drain is externalized through a separate stab incision.
Chevron Incision (Bilateral Subcostal Approach)
The chevron incision, essentially a bilateral anterior subcostal approach, is advantageous for renovascular surgery and radical nephrectomy with IVC tumor thrombectomy. Exposure of the renal pedicles and great vessels is outstanding. The incision starts at the tip of the 11th rib, extends approximately two fingerbreadths below and parallel to the costal margin, curves superiorly in the midline, travels parallel to the contralateral costal margin, and terminates at the tip of the contralateral 11th rib.
After dividing the subcutaneous tissues with electrocautery, the latissimus dorsi muscle, external oblique muscle, anterior rectus sheath, rectus abdominis muscle, internal oblique muscle, transversus abdominis muscle, posterior rectus sheath, and transversalis fascia are divided. The peritoneum is opened, dividing the ligamentum teres as described previously.
The peritoneum is closed with 2-0 polyglactin. The fascia is closed with 1-0 polydioxanone or 2-0 nylon. After bringing the subcutaneous tissues together with 3-0 plain sutures, the skin edges are reapproximated with staples or subcuticular 2-0 polyglactin. A Penrose drain is externalized through a separate stab incision.
Key Points: Surgical Approaches
Surgery for Benign Disease
Simple Nephrectomy
Indications
Simple nephrectomy, removal of the kidney within the Gerota fascia, is employed to manage nonmalignant diseases of the kidney. Indications for simple nephrectomy include durable nonfunction or poor function of a kidney due to obstruction, infection, trauma, stones, nephrosclerosis, vesicoureteral reflux, polycystic kidney, or congenital dysplasia. Nephrectomy is undertaken when reconstructive procedures have failed or are contraindicated due to poor function of the renal unit, advanced age, or significant comorbidity. Simple nephrectomy of a functional kidney may be employed to relieve intractable symptoms or associated problems, such as bleeding, pain, hypertension, or persistent infection. Simple nephrectomy is an accepted treatment for renovascular hypertension that is refractory to other organ-sparing therapies.
Preoperative Evaluation and Preparation
In addition to a genitourinary history, one must ascertain the patient’s full medical history, with a special focus on cardiovascular, pulmonary, and surgical history. Factors influencing choice of incision should be elucidated on history and examination, including body habitus and sites of prior abdominal or flank operations. One must be cognizant of a patient’s renal status and the anticipated function that will remain after surgery. Estimation of global renal function as previously described is essential. Determination of differential renal function by radionuclide scan is advisable, particularly if renal dysfunction or abnormal split function is suspected.
Techniques
Simple nephrectomy can be performed through the flank and anterior abdominal approaches as described earlier. The approach can be either extraperitoneal or transperitoneal. Removal of atrophic kidneys with end-stage disease can also be accomplished through a dorsal lumbotomy incision (Andaloro and Lilien, 1975; Novick, 1980). For all approaches the key steps of a simple nephrectomy are the approach, mobilization of the kidney, division of the artery followed by the vein, division of the ureter, removal of the kidney, and closure.
Standard Flank Approach
A flank approach (Fig. 54–38) is preferable in patients with multiple prior anterior abdominal operations and in obese patients. An extraperitoneal approach is preferred in patients with an infected renal unit or numerous prior transperitoneal procedures. The kidney can be approached extraperitoneally through the subcostal route, although consideration should be given to a supracostal approach depending on the patient’s anatomy.

Figure 54–38 A to D, Technique of simple left nephrectomy through an extraperitoneal flank incision.
The perinephric space is entered. To avoid inadvertent entry into the peritoneum a vertical incision is made in Gerota fascia on the lateral aspect of the kidney, revealing the underlying perinephric fat. The kidney is mobilized sharply by developing a plane between the renal capsule and the perinephric fat. If there have been numerous episodes of pyelonephritis or prior renal operations, developing this plane can be challenging. Inadvertent entrance into the renal capsule should be avoided. When developing the plane at the lower pole the ureter is identified but not yet ligated. Downward traction on the kidney permits the upper pole to be mobilized. The adrenal gland is left in position.
With the use of lateral traction on the kidney to expose the hilum, the vascular pedicle is dissected free from surrounding fat and lymphatics. The renal hilum can be approached either anteriorly or posteriorly. In the anterior approach, gonadal, adrenal, and lumbar branches draining into the left renal vein are ligated and divided. The mobilized renal vein is retracted to reveal the renal artery located posteriorly (see Figs. 54-8 and 54-39). The left renal artery should be differentiated from the superior mesenteric artery by ensuring that the renal artery emanates from the lateral aspect of the aorta and by palpating the superior mesenteric artery before ligating the renal artery. The renal artery is ligated away from the hilum using two medium vascular Hem-o-Lok clips on the stump side and a 2-0 silk tie on the specimen side. The artery is divided proximal to the silk tie. The arterial stump is then suture ligated with 2-0 silk. After division of the renal artery, the renal vein is similarly ligated and divided. In the posterior approach the artery is encountered before the renal vein and is ligated and divided before mobilization of the vein. The ureter is doubly clamped and divided. The specimen is removed. The distal aspect of the transected ureter is suture ligated with 2-0 polyglactin.

Figure 54–39 Ligation of adrenal and gonadal vessels and retraction of renal vein exposing main renal artery. IVC, inferior vena cava; Ao, aorta.
(© The Lahey Clinic.)
Ideally, the renal artery and vein are ligated individually as described previously, because taking the vessels en bloc may increase risk of arteriovenous fistula (Lacombe, 1985; Okamoto et al, 2001). In cases complicated by severe fibrosis and scarring, one may not be able to safely control the vessels individually, in which case en-bloc ligation and division may be necessary. A drain is brought out through a separate stab incision.
Subcapsular
In patients with a history of significant renal infection or prior renal surgery, severe inflammation and scarring may obliterate the usual tissue planes within the Gerota fascia, rendering mobilization of the kidney unsafe and inefficient. In these cases a subcapsular nephrectomy is indicated (Kimbrough and Morse, 1953; Kittredge and Fridge, 1958) (Fig. 54–40).
Subcapsular nephrectomy can be an arduous procedure. In patients who had prior renal surgery, care should be taken in entering the retroperitoneal space because the perirenal fat may be attenuated and the parenchyma can be unintentionally incised when opening the transversalis fascia. After entry into retroperitoneal space and determination that scarring precludes traditional simple nephrectomy, the renal capsule is incised longitudinally over the convex surface of the kidney.
Holding sutures of 2-0 polyglactin or Allis clamps are placed on the anterior aspect of the renal capsule for traction. While gently pulling on the anterior edge of the renal capsule and proceeding toward the hilum, sharp dissection is used to free the capsule from the underlying parenchyma. When the capsular flap has been raised adequately to expose the hilum, the parenchyma of the kidney is retracted laterally to expose the renal vessels. The artery and vein are ligated and divided in succession. The ureter is ligated and divided. The kidney is removed. Any devascularized perirenal tissue is excised. A drain is essential.
Transperitoneal Anterior Abdominal Approach
A transperitoneal anterior abdominal approach is used to perform simple nephrectomy in patients with renal trauma, flank scarring from prior operations, for bilateral nephrectomies, and in patients who are unable to tolerate the flank position. After making a transperitoneal midline incision or anterior subcostal incision, the Gerota fascia and the renal hilum are approached as described earlier. A Bookwalter retractor is employed. The Gerota fascia is entered medially and the hilum secured before mobilizing the kidney. On the left, retraction of the left renal vein inferiorly exposes the left renal artery, which is then ligated with 2-0 silk (see Fig. 54–39). For right nephrectomy, the right renal artery is ligated between the aorta and IVC (see Fig. 54–8). After securing the artery the renal vein is ligated and divided. After ligating the renal artery a second time, it is divided. The kidney is then mobilized within the Gerota fascia, the ureter is ligated and divided, and the specimen is removed. A drain is brought out through a separate stab incision.
Renovascular Surgery
Background
Renal artery surgery was first described in 1949 by Dos Santos for atherosclerotic disease utilizing a dedicated renal endarterectomy to treat an occlusive plaque. By restoring flow to the affected renal unit it became apparent that patency could be accomplished by removal of the intima and media of the arterial system. The drawbacks to this approach stemmed from the weakness of the native adventitia and the incidence of intimal flaps leading to postoperative aneurysms and restenosis. To maximize the repair surgeons soon came to recognize the benefits of vein patch renal angioplasty, thereby limiting narrowing and dilation. Transaortic endarterectomy was explored as an alternative option, allowing simultaneous repair; however, the high rates of recurrent stenotic disease precluded it becoming a mainstay in therapy (Libertino, 1992).
Renal endarterectomy and repair with saphenous vein or synthetic graft can be a suitable option for short well-defined segments of mural dysplasia. Recurrent stenosis is often attributed to residual microscopic mural disease not appreciated at the time of surgery. The authors prefer to treat renal stenotic lesions using aortorenal bypass procedures. If the saphenous vein is unavailable, cephalic vein or PTFE is recommended. In some instances the aorta is too diseased for reimplantation and alternate arterial conduits are chosen, as described later.
Etiology
The primary disease entities necessitating revascularization include atherosclerosis (75%) and fibrous dysplasia (25%). Patients can present with hypertension and renal insufficiency when the lesion is chronic. Less than 3% of the hypertensive population has a renovascular etiology versus an estimated 18% to 20% in patients undergoing cardiac angiography and 35% to 50% of patients with aortic occlusive disease (Olin et al, 1990; Anderson et al, 1994; Rihal et al, 2002). Hypertension is a direct result of activation of the renin-angiotensin-aldosterone system, whereas renal impairment (ischemic nephropathy) is secondary to reduced perfusion pressure and loss of glomerular filtration capacity.
Atherosclerosis
In general, atherosclerosis affects patients in the sixth to seventh decades of life. The diagnosis of renovascular hypertension caused by atherosclerosis is being discovered in younger patients, which may be attributable to increased imaging studies. Atherosclerosis may be limited to the renal artery in 15% to 25% of patients but tends to be part of a generalized process affecting the major arterial branches of the aorta. Bilateral disease is present in up to 40% of patients (Fig. 54–41). Unilateral disease is more common in the left renal artery with contralateral disease present in 40% at the 4-year mark (Libertino et al, 1988). Although renal arteries are end arteries by anatomic definition, the slow onset of atherosclerosis permits development of collateral vessels, resulting in minimal clinical symptoms.
Mural Dysplasia
Fibrous dysplasia is progressive and more common in children and young adults. Segmental stenotic sections develop secondary to hyperplasia of smooth muscle and the associated layers of the arterial wall. Various categories exist under the broad definition of fibrous dysplasia.
Primary intimal fibroplasia accounts for 10% of lesions and occurs in children and young adults. The process can develop in contralateral kidneys or other vessels in a progressive nature. Angiographically the disease has smooth, focal stenosis involving the proximal or middle portion of renal vessels or branches (Fig. 54–42).

Figure 54–42 Intimal fibroplasia.
(From Libertino JA. Reconstructive urologic surgery. 3rd ed. Philadelphia: Mosby; 1997.)
Medial fibroplasia accounts for 75% to 80% of fibrous lesions primarily in women between 25 and 50 years of age. With angiography, arteries demonstrate a “string of beads” in the distal two thirds of the main renal artery and its branches (Fig. 54–43). Multiple microaneurysms can also be appreciated. An estimated 33% demonstrate progression, whereas complete occlusion is rare.

Figure 54–43 Selective right renal angiogram demonstrating medial fibroplasia “beads on a string” in a solitary right kidney.
Perimedial (subadventitial) fibroplasia accounts for 10% to 15% of fibrous lesions and is limited to the renal arteries. Angiographically the appearance is similar to that of medial fibroplasia but there are no microaneurysms and extensive collateral circulation is present (Fig. 54–44). Without intervention this entity leads to severe stenosis and progressive obstruction with ischemic nephropathy. The disease often afflicts young females.

Figure 54–44 Selective right renal angiogram demonstrating perimedial (subadventitial) fibroplasia with decent collateral vasculature.
Fibromuscular hyperplasia is an extremely rare lesion, accounting for less than 5% of mural dysplasia in children and young adults. These lesions progress over time. Although most of these lesions can mimic one another the final diagnosis should be made after histologic examination when possible.
Renal Aneurysms
Aneurysmal disease can lead to progressive renal damage and hypertension. By definition these lesions may be true (congenital or acquired) or false from trauma. Angiographically they can be divided into saccular, dissecting, fusiform, and intrarenal. Saccular forms occur in the main renal artery or at the anterior-posterior branch point and are the most common (Fig. 54–45). Dissecting aneurysms result from a disruption of the internal elastic membrane in certain populations (e.g., atherosclerosis, intimal fibrodysplasia, and perimedial fibrodysplasia). Fusiform aneurysms are noncalcified and common in younger hypertensive patients with fibromuscular dysplasia (Fig. 54–46).

Figure 54–45 Saccular aneurysm in left renal artery (atherosclerosis).
(From Libertino JA. Reconstructive urologic surgery. 3rd ed. Philadelphia: Mosby; 1997.)

Figure 54–46 Fusiform aneurysms in right renal artery.
(From Libertino JA. Reconstructive urologic surgery. 3rd ed. Philadelphia: Mosby; 1997.)
Intrarenal aneurysms are considered congenital and account for one fifth of aneurysmal disease affecting the kidney (Fig. 54–47). In some instances they may develop secondary to atherosclerosis, mural dysplasia, trauma, inflammation (arteritis), or needle biopsy. Intervention is warranted for lesions larger than 2 cm or those associated with hypertension. Lesions can rupture and dissect leading to ischemia or may contribute to thrombus formation and warrant intervention (revascularization or coil placement). Women in childbearing age with evidence of aneurysms are urged to undergo repair secondary to risk of rupture and associated high rates of maternal and fetal mortality (Figs. 54-48 and 54-49) (Yang and Hye, 1996; Centenera et al, 1998).

Figure 54–47 A, Large left congenital renal aneurysm and arteriovenous malformation. B, Note early filling of the renal vein and inferior vena cava.
Embolic Disease
Embolic disease affecting the arterial tree is often secondary to migration of cardiac thrombus from underlying atrial fibrillation, acute myocardial infarction, ventricular aneurysms, subacute bacterial endocarditis, mitral valve disease, prosthetic valves, and cardiac tumors (myxomas). Paradoxical emboli can arise from VTE via patent foramen ovale. Iatrogenic emboli can arise during manipulation of atherosclerotic vessels during aortic surgery or angiographic procedures. Emboli commonly migrate to the left renal artery because of its acute angle from the aorta.
Management of emboli is often time dependent in terms of renal salvage, and patients are best treated with thrombolysis or percutaneous transcatheter embolectomy. Emboli affecting solitary kidneys or both kidneys need to be treated by thrombolysis (e.g., streptokinase) and catheter embolectomy. Surgical intervention is based on clinical response to conservative measures and the complexity of the case.
Trauma
Blunt or penetrating renal trauma, iatrogenic in some cases, can rarely cause acute renal artery thrombosis. Blunt trauma more frequently involves the left renal artery. Isolated injury is infrequent, and most of these patients have other associated injuries (extremity or rib fractures with pneumothorax or hemothorax or hepatic and splenic lacerations or contusions). Because of its rigidity the intima is torn, resulting in hemorrhage and propagation of thrombus. The adventitia and media, which are more elastic, will stretch. In general, patients with traumatic renal artery thrombosis only should undergo an attempt at surgical repair in the presence of a solitary kidney or bilateral occlusion. Unfortunately, therapy for traumatic renal artery thrombosis is often unsuccessful even when performed within a short time after the injury.
Arteriovenous Malformations
Arteriovenous malformations may be congenital or acquired with a wide range of symptoms. High-output cardiac failure from arteriovenous malformations in renal cell carcinomas have been described (Crawford et al, 1979). In cases of renal tumors, preoperative angioembolization may help restore cardiac integrity before nephrectomy (see Figs. 54-16 and 54-17). Iatrogenic causes include renal artery biopsy, partial nephrectomy, radiofrequency ablation, and cryotherapy. Percutaneous approaches are highly successful for treating these lesions. Open surgery is rarely required for these renovascular lesions and when indicated is often in the form of a nephrectomy.
Takayasu Disease
Takayasu inflammatory disease is characterized by localized periarteritis with mononuclear infiltration, multinucleated giant cells, and disruption of elastic arterial wall fibers. Although the disease has been primarily associated with patients of Asian descent, it is now known to coexist in the Western world. Takayasu arteritis typically affects young women (80% of affected patients are younger than 35 years old). Takayasu disease was initially described for its ocular findings. Clinicians later discovered that its arterial lesions were more widespread than initially thought. For diagnostic and surgical reasons it has been classified angiographically into four categories based on the location of the lesions: (1) aortic arch and its great vessels, (2) descending thoracic and upper abdominal aorta, (3) simultaneous involvement of categories 1 and 2 (65% of all cases), and (4) pulmonary artery with or without categories 1 through 3. Of the cases reported in the literature, 50% are associated with hypertension. Renal artery disease is most common, followed by proximal hypertension caused by coarctation of the aorta and loss of arterial elasticity (Fig. 54–50) (Ishikawa, 1978).
Neurofibromatosis
Neurofibromatosis is a hereditary disease characterized by café-au-lait spots, cutaneous fibromas, and neurofibromas. Hypertension associated with neurofibromatosis is usually caused by pheochromocytoma or, more rarely, by coarctation of the aorta. Arterial lesions associated with neurofibromatosis have been reported occasionally since the first published report in 1905. Renovascular hypertension associated with neurofibromatosis has been described in 20 cases, 18 of which were in children. The vascular lesions are characterized by intimal endothelial nodules in the vessel wall. The aorta is frequently involved, and the renal arteries may demonstrate long areas of stenosis, which are probably best treated by revascularization procedures rather than by angioplasty.
Management Options
The gradual decline in renal revascularization procedures is a testament to improved medical management and appropriate population based on imaging screening protocols. Advances in percutaneous transluminal angioplasty and renal artery stent development have lessened the need for open renal bypass surgery, respectively.
Medical Therapy
By the time of referral most patients have been on multiple drug therapy (angiotensin-converting enzyme [ACE] inhibitors, angiotensin receptor blockers and β-adrenergic blockers) targeted at the renin-angiotensin and aldosterone cascades. ACE inhibitors manage hypertension and provide a means to predict who will benefit from surgery (e.g., ACE inhibitor test, captopril-furosemide renogram). Medical management is best targeted at lesions least likely to progress to complete occlusion and ischemic nephropathy, such as medial fibroplasia.
It is important to reiterate that although ACE inhibitors can improve hypertension there is little evidence to support their role in delaying progression of occlusive disease process. An inadvertent consequence of ACE inhibitors is a reduction in GFR by eliminating angiotensin II–induced efferent arteriolar constriction. In patients with bilateral disease or solitary kidneys there will be a paradoxical increase in blood pressure secondary to increased renin secretion and azotemia.
Interventions
Indications for surgical or percutaneous (angioplasty or stenting) intervention are listed in Table 54–9. In general, patients who have elevated creatinine levels, poor functional studies, or unfavorable histology are unlikely to benefit from revascularization.
Table 54–9 Indications for Surgical or Percutaneous Intervention
ACE-I, angiotensin-converting enzyme inhibitor; ARB, angiotensin receptor blocker; GFR, glomerular filtration rate.
Patients with high significant risk factors are better suited with endovascular repair. Percutaneous approaches (angioplasty and stenting) are ideal approaches for short, nonostial, nonoccluded lesions in the proximal or mid main renal artery often found in fibromuscular dysplasia. As a general rule, stents can be used for bilateral atherosclerotic disease or solitary kidneys in patients unable to tolerate open surgery. Open repair is indicated in failed endovascular repairs or when concomitant aortic repair is undertaken.
Preoperative Evaluation
In general, renovascular candidates can be divided into two groups: atherosclerosis and mural dysplasia. The former population is older with multiple comorbidities. The high incidence of concomitant carotid and coronary artery disease warrants evaluation with angiography or 3D CT angiograms. Preoperative revascularization via percutaneous stenting is preferable to limit morbidity associated with recovery. Simultaneous procedures are ill advised and performed under the rarest of circumstances. Percutaneous procedures have a 1% to 3% incidence of dissection requiring open repair, and the authors therefore recommend full workup in case conversion is necessary. Recommended noninvasive options for evaluation include duplex Doppler ultrasonography, captopril-enhanced renal scans, and magnetic resonance angiography. Although angiography remains the gold standard the nephrotoxic risk may be too high.
Endovascular Procedures
Percutaneous transluminal angioplasty was first performed in 1964 by Dotter and Judkins for peripheral vascular disease and expanded to the renal arterial system by Gruntzing and Hopff 10 years later (Dotter and Judkins, 1964; Gruntzig and Hopff, 1974). Technical advances and an aging population have resulted in aortic and renal open revascularization rates decreasing 73% from 1998 to 2001 while percutaneous procedures increased by 173% (Knipp et al, 2004).
Percutaneous transluminal angioplasty is now a widely used technique for treatment of patients with renal artery disease. Little controversy exists about its role in the treatment of patients with fibromuscular dysplasia. The results reported are excellent and are comparable to those obtained by surgical revascularization. In up to 30% of patients, mural dysplasia involves the arterial branch points, which increases the technical difficulties of balloon dilation and often renders it impossible to perform.
Several factors influence the success of transluminal angioplasty in patients with atherosclerotic renal artery stenosis. In this population, the success rate associated with nonostial lesions is 80% to 85%. For unilateral ostial lesions and lesions that originate within the aorta, patency rates average only 30% to 35%. Patients with total renal artery occlusion, bilateral involvement, and renal artery aneurysms are not considered candidates for percutaneous transluminal renal angioplasty (PTRA) because of historically poor response rates (Novick, 1994).
Complications associated with PTRA were reported in 10% of patients. The most frequently reported complications are main renal artery dissection, thrombosis and occlusion, segmental artery infarction, and hematoma (Eklof et al, 2009). Pseudoaneurysms are also a recognized risk. Thus, although the procedure is performed under local anesthesia, all patients must be considered as preoperative for open repair. With this in mind, patients require a comprehensive preoperative evaluation and postoperative observation. In addition, it is the authors’ practice to have an operating room available and urology and anesthesiology teams aware of the procedure in the event open repair is required.
Open Surgical Repair
Aortorenal Bypass
The widespread popularity of the aortorenal bypass graft for renal artery disease stems from its technical ease of insertion and favorable short-term and long-term patency rates (see Fig. 54–51 on the Expert Consult website![]() ). The procedure eliminates the hazardous dissection of the juxtarenal aorta required with endarterectomy, and overall patency rates range from 94% to 99% (Libertino et al, 1980). Almost all disease processes affecting renal artery patency, particularly the fibrodysplasias, may be bypassed with an aortorenal graft (Figs. 54-52 and 54-53). One notable exception is severe atherosclerotic disease that renders the aorta an unsafe vessel from which to obtain blood flow. In this instance, alternative bypass procedures are indicated (Libertino and Selman, 1982).
). The procedure eliminates the hazardous dissection of the juxtarenal aorta required with endarterectomy, and overall patency rates range from 94% to 99% (Libertino et al, 1980). Almost all disease processes affecting renal artery patency, particularly the fibrodysplasias, may be bypassed with an aortorenal graft (Figs. 54-52 and 54-53). One notable exception is severe atherosclerotic disease that renders the aorta an unsafe vessel from which to obtain blood flow. In this instance, alternative bypass procedures are indicated (Libertino and Selman, 1982).

Figure 54–52 Right renal angiogram demonstrating significant mid renal artery stenosis from subadventitial disease. Note extensive adrenal collateral and distal reconstitution.

Figure 54–53 Postoperative angiogram demonstrating patent right renal artery after end-to-end saphenous vein aortorenal bypass.

Figure 54–51 A and B, Aortorenal bypass using autogenous saphenous vein graft.
(A, © The Lahey Clinic.)
The autogenous saphenous vein has emerged as the preferred graft in adults and is the most common graft material used for restoration of renal blood flow at the Lahey Clinic. Saphenous vein is readily available and closely approximates the size of the renal artery. The intima is less thrombogenic than prosthetic material and accommodates the creation of a precisely contoured anastomosis with a delicate thin-walled distal renal artery. Patent anastomoses can be achieved with 2- to 3-mm lumen branches beyond the major bifurcation. When saphenous vein is not available, the authors’ prefer to use cephalic vein or PTFE graft (Libertino and Zinman, 1980).
In children, autogenous hypogastric artery is the most favorable graft material with which to revascularize the renal artery. Its size approximates that of the renal artery, and its intima is free of fibromuscular disease. The saphenous vein should never be used in this population because it is too small and readily undergoes aneurysmal dilation. Conversely, the hypogastric artery in older adults is usually heavily involved with atheroma and thus is not a suitable graft material.
The procurement of an adequate segment of the greater saphenous vein is critical to the success of the bypass procedure. Meticulous technique in exposure and excision of the vein is essential to prevent mural trauma and ischemia and associated stenosis and dilatation in the long term. The contralateral vein is harvested, allowing two surgical teams to work simultaneously. The vein is mobilized through a single long incision in the upper thigh beginning parallel and caudal to the groin crease (Fig. 54–54). When the femoral artery is palpable, the incision is made directly over the pulsation; otherwise, the incision is 2 to 3 cm lateral and caudal to the ipsilateral pubic tubercle. After the junction of the saphenous and femoral veins has been exposed the incision is extended toward the knee directly over the vein. Finger dissection between the vein and the overlying skin is helpful to ensure accurate placement of the incision, to prevent the development of potentially necrotizing skin flaps. The ideal graft is 20 cm long with an outside diameter of 4 to 6 mm. Excess vein should always be available for revision of any intraoperative technical problems that may occur during anastomosis. The areolar tissue is not dissected from the specimen, and the adventitia is left undisturbed. To decrease transmural ischemia the vein graft remains in situ until the renal vessels are mobilized and it is ready to be used. If the graft is removed prematurely, it is placed in cold lactated Ringer solution or autologous blood, even if only for a short time. The caudal end of the vein is cannulated with a Marks needle secured with a fine silk. The vein is flushed with dilute heparinized saline solution, and the cephalic end is secured with a microvascular Schwartz clamp (Fig. 54–55). The vein is distended to a minimal diameter of 5 to 6 mm and transected with Potts scissors. The in-situ vein remnant is secured with a silk suture ligature. The thigh incision is not closed until the bypass procedure is completed to ensure that any delayed bleeding resulting from heparinization is identified and controlled.
Technique for Insertion of Saphenous Vein Graft
Systemic heparin is administered about 30 minutes before clamping the arteries. The saphenous vein graft should be oriented properly to avoid misalignment during implantation. The proximal end with Marks needle is transected with Potts scissors. Either an end-to-end or end-to side anastomosis may be performed distally, depending on the anatomy encountered. For aortorenal bypass the proximal anastomosis is obviously always end to side. A distal end-to-end anastomosis is preferred because it permits the best laminar flow.
The aorta, having been exposed widely from the level of the renal arteries to the inferior mesenteric artery, is gently palpated to locate a suitable soft location for the anastomosis. A medium-sized side-biting vascular clamp is placed on the anterolateral portion of the infrarenal aorta in a tangential manner. A vertical 13- to 16-mm aortotomy is made without excising the aortic wall or attempting to perform localized endarterectomy. The former is unnecessary because intraluminal aortic pressure will spread the edges of the linear aortotomy to the appropriate dimensions when the clamp is released. The vein graft is anastomosed to the aorta with two continuous sutures of 5-0 polypropylene after it has been spatulated (Fig. 54–56). A microvascular clamp is placed on the end of the saphenous vein graft, and the aortic clamp is released. The graft is permitted to lie anterior to the vena cava on the right side or anterior to the renal vein on the left side. Although it is preferable to leave the vein too long rather than too short, it should not be so long as to bend into an acute angle at any point. The renal artery is secured distally with a smooth-jawed microvascular clamp(s) placed on either the main artery or a segmental branch. The proper site for the arterial anastomosis is selected. An end-to-end anastomosis is performed using continuous or interrupted sutures of 6-0 polypropylene (see Fig. 54–51 on the Expert Consult website![]() ). When the recipient vessel is 3 mm or less in diameter, interrupted sutures are used exclusively. Likewise, an interrupted suture line is used in children to prevent “purse-string stenosis” as their vessels grow. Although the authors usually perform an interrupted anastomosis even in adults, continuous suture lines may be run between interrupted sutures at four quadrants without the danger of “purse-string stenosis.” Bleeding from needle holes at the anastomosis can usually be controlled with thrombogenic mesh such as Surgicel (Ethicon, Somerville, NJ). Multiple grafts can be employed when disease affects kidneys with more than one renal artery (Fig. 54–57; see Figs. 54-51 and 54-58 on the Expert Consult website
). When the recipient vessel is 3 mm or less in diameter, interrupted sutures are used exclusively. Likewise, an interrupted suture line is used in children to prevent “purse-string stenosis” as their vessels grow. Although the authors usually perform an interrupted anastomosis even in adults, continuous suture lines may be run between interrupted sutures at four quadrants without the danger of “purse-string stenosis.” Bleeding from needle holes at the anastomosis can usually be controlled with thrombogenic mesh such as Surgicel (Ethicon, Somerville, NJ). Multiple grafts can be employed when disease affects kidneys with more than one renal artery (Fig. 54–57; see Figs. 54-51 and 54-58 on the Expert Consult website![]() ).
).

Figure 54–56 Aortic-to-graft anastomosis is carried out before graft-to-renal artery anastomosis when an end-to-end anastomosis is desired. Ao, aorta.
(© The Lahey Clinic.)

Figure 54–57 Aortogram demonstrating right upper pole renal artery occlusion and lower pole aneurysm at the bifurcation. The patient was treated with dual saphenous vein aortorenal bypass grafts.
Native saphenous vein and arterial autografts have been shown in many clinical studies to preserve glomerular function, and patency has been confirmed with postoperative angiography. PTFE grafts have been shown to be a feasible option in renal revascularization with concomitant aortic replacement. Customized grafts can compensate for discrepancies in anastomotic sizes. Seven-year patency rates of over 95% have been reported by Paty and associates (2001) in more than 400 revascularization procedures.
Alternatives to Aortorenal Bypass
The authors often make use of the internal iliac artery to repair lesions of the segmental renal arteries. Extensive collateral flow to the pelvis enables one to use this arterial conduit. An anterior subcostal with modified Gibson incision is the senior author’s preferred approach. Alternatively, an anterior midline incision may by used for both renal artery mobilization and harvesting of the internal iliac artery. Evidence of atherosclerosis in the graft is a contraindication. Vessel loops are placed at proximal and distal branch point locations (Fig. 54–59). The artery is harvested by a second team as the primary team is nearing completion of their bench component. The hypogastric artery and branches are tailored to accommodate the branch points of the disease segments, and end-to end anastomoses are performed using 6-0 and 7-0 polypropylene suture (Fig. 54–60). The kidney is then autotransplanted into the groin as described in later sections.
Patients with diffuse atherosclerosis, significant aortic disease or prior aortic surgery, and left renal arterial disease are candidates for a splenorenal artery bypass. Preoperative lateral and oblique angiography should confirm the absence of disease of the celiac axis. CT reconstructions in combination with MRI have replaced angiography in some cases. Calcification of the distal splenic artery is a rare finding that would obviously preclude its use for repairs. The native state of the splenic artery provides an ideal location for bypass requiring only one anastomosis. Intraoperative use of ultrasound is suggested to establish blood flow rates, and at least 125 mL per minute is recommended.
The initial exposure is through a supracostal 11th incision. This incision permits a retroperitoneal approach without entry into the pleural cavity. The planes between the adrenal and kidney (within Gerota fascia) posterosuperiorly and between the kidney and pancreas anteromedially are entered with sharp dissection using tenotomy scissors. Manipulation of the pancreas should be avoided when identifying the splenic artery at its superior border. The artery is next mobilized from the splenic hilum to the celiac plexus without violating the peritoneal space (Fig. 54–61). Branches to the pancreas are ligated using 4-0 silk suture, and a Schwartz clamp is placed at the origin of the splenic artery. One may increase the caliber of the lumen using a Fogarty balloon, Gruntzig balloon catheter, or coronary artery dilators. The artery is next divided in close proximity to the hilar bifurcation point. Collateral blood flow from the short gastric eliminates the need for a splenectomy.
The left kidney is mobilized within the retroperitoneum. The authors recommend isolating the arterial supply via the posterior approach to avoid the superior mesenteric artery. Once adequate length is obtained the vessels are anastomosed in an end-to-end fashion with interrupted or continuous 6-0 polypropylene sutures (Fig. 54–62). After completion of the anastomoses, Surgicel may be placed to promote hemostasis around needle entry points. Saphenous vein interposition grafts can be employed to eliminate tension between the splenic and left renal artery if necessary (Fig. 54–63).

Figure 54–63 A, Aortogram demonstrating left renal artery stenosis, diseased aorta, and patent splenic artery. B, Splenorenal bypass using saphenous vein interposition graft. C, Postoperative selective aortogram.
Postoperatively, patients are maintained on heparin. Postoperative Doppler studies or a 99mTc-mercaptoacetyltriglycine (MAG3) renogram may be used to evaluate renal perfusion. Complications include thrombosis and graft failure. Pancreatitis and associated pancreatic pseudocysts have occurred in a small subset of over 175 splenorenal bypass patients treated at the Lahey Clinic.
Hepatorenal and Gastroduodenal Artery Bypass
The indications for alternatives to aortorenal bypass for right-sided lesions are similar to those for the contralateral side and can be managed with hepatorenal or gastroduodenal saphenous bypass grafts as have been described by the authors’ group (Libertino and Lagneau, 1983, Libertino et al, 1976). The common hepatic artery arises from the celiac plexus coursing laterally above the head of the pancreas until the confluence of the portal vein complex before branching into ascending and descending limbs. The ascending portion lies medial to the biliary tree and in front of the portal vein before branching into the right and left proper hepatic arteries. The descending limb becomes the gastroduodenal artery and can also be used in certain situations.
Variation within the hepatic arterial tree is almost twice that in the renal system, with an estimated 48% of living liver donors having aberrant vasculature (Hiatt et al, 1994). In addition to a sound understanding of the anatomy the surgeon must be patient during dissection of the porta hepatis, making every effort to spare all arterial components. Accessory arteries will hypertrophy in response to the loss of the common hepatic artery.
Unlike on the left side, the transabdominal approach is necessary for right-sided repairs. The right renal artery is identified and dissected under the IVC as close to the aorta as possible. The common and proper hepatic arteries are isolated and clamps placed before dividing the gastroduodenal artery. A 10- to 12-mm arteriotomy is made in the inferior wall of the hepatic artery at the ostium of the gastroduodenal artery. A reversed autogenous saphenous vein graft is sewn between this and the renal artery using interrupted or continuous 6-0 polypropylene (Fig. 54–64; see Fig. 54–65 on the Expert Consult website![]() ).
).
In rare instances a patient requiring open surgical revascularization may not be able to undergo aortorenal, splenorenal, or hepatorenal bypass surgery and an alternative such as the ileorenal bypass may be needed (Fig. 54–66). Unfortunately most patients with significant atherosclerosis of the renal aorta have equivalent disease at the level of the common iliac arteries. Progression of iliac atherosclerosis may lead to chronic ischemia of kidneys undergoing this form of revascularization. A midline incision is made, and a saphenous vein graft harvest performed. The corresponding colon is mobilized along the line of Toldt from the splenic or hepatic flexure to the iliac vessels. Utilization of the contralateral iliac artery is an option if significant ipsilateral disease is present. Vessel loops and vascular clamps are used in standard fashion to perform an end-to-side anastomosis at the iliac vessel and end-to-end technique at the renal artery using 6-0 polypropylene suture (Figs. 54-67 and 54-68; see Fig. 54–69 on the Expert Consult website![]() ).
).

Figure 54–66 Iliac artery to renal artery saphenous vein bypass graft—an alternative to autotransplantation. Ao, aorta.
(© The Lahey Clinic.)

Figure 54–67 A, Preoperative angiogram. B, Right ileorenal bypass using sequential saphenous vein grafts. C, Postoperative angiogram with restored flow to the right kidney.
If the splenic artery is heavily atherosclerotic, a thoracic aortorenal bypass is an option. The subdiaphragmatic supraceliac and descending thoracic aorta is often free of atherosclerosis and can serve as an alternative for renal vascular reconstruction using a saphenous vein graft. Preoperative angiography to rule out disease at this level is essential. Novick (2007) describes using a supra–9th rib incision extending across the midline for left-sided lesions. The cephalad extent of the incision provides great exposure of the thoracic aorta and left renal artery. The left colon is reflected medially in standard fashion to expose the renal artery in the retroperitoneum. After exposure of the thoracic aorta a DeBakey clamp is used to partially occlude a lateral segment before making a small aortotomy. A reversed autogenous saphenous vein graft is then sewn in an end-to-side fashion. Systemic heparinization is not employed because the aortic flow is preserved (Fig. 54–70). The hiatus in the diaphragm is extended by 2 cm laterally, permitting passage of the saphenous vein behind the pancreas into the retroperitoneal space. An end-to-end anastomosis is performed to the left renal artery. For right-sided lesions the subdiaphragmatic supraceliac and lower thoracic aorta can be accessed via an anterior bilateral incision. The steps are repeated in a similar fashion to the left-sided approaches.
Thoracic inlet revascularization of the renal system has several advantages. The high flow thoracic aorta in conjunction with the relatively acute angle of the proximal graft is hemodynamically advantageous and decreases the thrombogenicity that would be associated with sluggish arterial flow. The ability to perform the anastomosis without complete aortic cross clamping avoids systemic heparinization and spinal cord ischemia. Renal ischemia is limited to the time necessary to perform the distal vein-to-renal artery anastomosis, which rarely exceeds 25 minutes. Autogenous graft material limits the immune response associated with synthetic material.
Novick (2007) reports resolution or improvement of hypertension in 86% of his surgical population with preservation or enhanced renal function in 95% within the same group of 23 patients. All patients demonstrated extensive atherosclerosis of the abdominal aorta and celiac artery stenosis precluding hepatic and splenic bypass.
The superior mesenteric artery has been utilized in conjunction with a saphenous vein interposition graft leaving the marginal artery of Drummond responsible for collateral circulation between the celiac and inferior mesenteric artery. Novick (2007) describes significantly enlarged superior mesenteric arteries associated with complete infrarenal aortic occlusion in which extensive collateral circulation provided insurance against bowel ischemia. Midline incisions provide excellent exposure for both right and left renal arteries. Exposure of the suprarenal aorta is obtained by cephalad retraction of the pancreas and first portion of the jejunum and medial refection of the mesocolon. The superior mesenteric artery can be palpated 2 to 3 cm above the renal arteries. This artery is mobilized 2 to 3 cm beyond the takeoff of the aorta. A reversed saphenous vein interposition graft is anastomosed end to side along the lateral aspect of the superior mesenteric artery. An end-to-end anastomoses is performed from the graft to the right or left renal artery (Fig. 54–71).
Renovascular Salvage Surgery
Despite the successful patency rates that have been achieved with endovascular approaches, occasional patients remain who will need an open salvage procedure in the setting of postoperative complications or recurrent disease (Lacombe and Ricco, 2006). Surgical dissection is complicated by inflammatory changes. Renal artery stents preclude thromboembolectomy. Wide resection with interposition vein patch angioplasty is the primary choice with alternate bypass as a reserve option. Fibromuscular revisions fare better than atherosclerotic ones owing to less inflammatory reaction and a generally healthier population.
Revascularization of an Occluded Renal Artery
Predictors of functional return after revascularization of an ischemic renal unit have been elucidated. The kidney with a totally occluded renal artery may be revascularized when the following criteria are fulfilled: angiographic demonstration of a nephrogram, proximal occlusion with retrograde filling of distal circulation by perihilar collateral vessels, intraoperative back-bleeding from a renal arteriotomy distal to the occlusion, and demonstration on intraoperative frozen section or preoperative biopsy of an intact glomerular architecture (Zinman and Libertino, 1973, 1977; Libertino et al, 1980) (Figs. 54-72 and 54-73).
Outcomes and Complications
Although open renovascular surgery has seen a significant decline in numbers, the success rates justify the role it continues to play in the treatment of renovascular hypertension. In more than 300 procedures performed at the Lahey Clinic the overall success rate is 85%, and other contemporary series produce similar results (Lawrie et al, 1989; Libertino et al, 1992). The surgeon who performs open renovascular surgery is now confronted with a greater number of failed percutaneous approaches, which tend to have lower revascularization success rates. These procedures can be technically demanding and should be performed by persons with a strong background in vascular surgery.
Early complications include hemorrhage, thrombosis, subintimal dissection, false aneurysm, and distal branch vessel embolization. Postoperative bleeding is often attributable to surgical technique or overzealous anticoagulation. Covering the anastomoses with thrombogenic material such as Surgicel can limit bleeding. Perihilar vasculature is often collateralized and deserves attention during mobilization. False aneurysm formation can lead to delayed bleeding, as can infected suture lines. Postoperative thrombosis if recognized early enough is best treated with anastomotic revision.
Intimal dissection can occur in significantly atherosclerotic vessels during suture placement. Sutures that pass from intima to adventitia in theory have a lower chance of disrupting plaque. Atheroemboli can travel after clamping or unclamping a diseased aorta, resulting in a pulseless extremity requiring thromboembolectomy.
Extirpative Surgery
Reconstructive surgery is preferable to nephrectomy, considering that the kidney is fundamentally healthy and both atheromatous and mural diseases are potentially bilateral entities. The major determinant in favor of nephrectomy is poor viability or nonviability of the affected renal unit. In the presence of failed medical therapy and significant medical comorbidity a nephrectomy should be the primary therapy. Patients with complete occlusion of previous placed grafts may undergo a trial of streptokinase or tissue plasminogen activator if the occlusion is discovered early enough (<6 hours). Nephrectomy may be the treatment of choice for restenosis after reconstruction when the occlusion is unresponsive to tissue plasminogen activator and there is marginal function. Nephrectomy is also a suitable option for those with extensive unilateral arterial disease at the segmental level (multiple branch-point lesions) in the setting of normal contralateral renal function.
Partial nephrectomy in this situation is based on the premise that the disease process is localized and that preservation of normal remaining nephrons is worth the increased operative time and surgical risk. Patients with branch lesions that produce segmental ischemia and localized overproduction of renin may be treated by arterial bypass when the segmental branch is large enough; by arteriotomy and dilation, especially in pediatric patients; or by partial nephrectomy with an upper, lower, or midsegmental renal resection. Knowledge of the segmental blood supply to the kidney is essential for proper performance of partial nephrectomy.
Midpolar partial nephrectomy may be useful in patients with segmental lesions that affect the superior or inferior branches of the anterior segmental renal artery (Fig. 54–74). Selective arteriography is essential to understand the arrangement and distribution of the anterior and posterior arterial branches. Venography and segmental venous renin assays are obtained from the venous branches draining the affected tissue. These tests are helpful when main renal vein renin levels do not lateralize.

Figure 54–74 A, Dissection technique in partial nephrectomy of the midsection. Tertiary arterial branches are dissected gently in the renal sinus aided by palpebral retractors of the Gil-Vernet type. Identification of a small blood vessel, such as one that supplies part of the diseased parenchyma, is achieved by injecting a diluted solution of indigo carmine dye into the lumen with a scalp vein needle and correlating the region stained with that seen angiographically. B, Excision is completed by division of tertiary vascular branches and of the infundibulum draining the involved calyx. C, Polar remnants are rejoined after releasing the arterial clamp and achieving hemostasis. Closure of the collecting system is tested with blue saline solution.
(© The Lahey Clinic.)
Key Points: Renovascular Surgery
Extracorporeal Renal Surgery and Autotransplantation
Background
The first successful renal autotransplant was recorded by J. D. Hardy in 1963 for ureteral disease. Since that time the indications for “renal bench” surgery have broadened and have resulted in improved clinical outcomes (Ota et al, 1967; Husberg et al, 1975; Putnam et al, 1975; Wotkowicz and Libertino, 2004). Complex renovascular disease, renal tumors, and staghorn calculi have been the mainstay of the authors’ experience. Extracorporeal partial nephrectomy was described more than 30 years ago for renal cell tumors and provides an alternative to dialysis in select patients. Laparoscopy has also been added to the field to help limit morbidity and speed recovery (Fabrizio et al, 2000; Meng et al, 2003).
Many of the initial feasibility studies were performed in canine models and gradually expanded to the human population (Belzer et al, 1970). Vascular repair of complex intrarenal disease is performed using native veins of saphenous, splenic, and iliac origin or hypogastric arterial grafts. The last is often best suited to pediatric or young adult populations with limited size discrepancy and a lack of atherosclerotic disease. Technical advances with respect to surgical magnification have expanded the indications. Overall renal insult associated with these complex procedures has been limited with advances in hypothermic perfusates commonly used in transplantation, which provide an isotonic external milieu (Belzer et al, 1992). In limiting membrane transport the metabolic requirements decrease while maintaining cellular integrity. In addition the cold solution shrinks parenchyma, leading to better vascular and collecting system exposure (Novick et al, 1979).
Indications
Most arterial disease requiring bench approaches have extension at and beyond the anterior and posterior division branch points (Fig. 54–75). Stenotic lesions and aneurysms may be resected and repaired with interposition saphenous vein grafts. Multiple branch lesions may be amenable to hypogastric artery interposition utilizing the branches of the internal iliac artery when atherosclerosis is absent. Renal tumors have also been removed utilizing an ex-vivo approach in select patient populations (solitary kidneys), with limited small volume series in the literature (Fig. 54–76) (van der Velden et al, 1992). The ureter can be affected by the numerous processes (trauma, iatrogenic, and inflammatory) that lead to urinary obstruction or extravasation. Left untreated, these patients develop chronic infections and eventual renal failure. Recurrent nephrolithiasis can lead to ureteral stenosis secondary to repeat trauma from ureteroscopy and scarring from percutaneous approaches. Indications for autotransplantation include tumors in solitary kidneys, recurrent staghorn calculus and concomitant renovascular disease, sterile urine and recurrent nephrolithiasis causing damage to a ureter, calculi associated with congenital abnormalities, or extensive ureteral stricture. Transitional cell carcinoma of the renal pelvis or ureter in solitary kidneys can be managed with this approach.

Figure 54–75 A, CT scan in a 33-year-old man with an atrophic left kidney and fibromuscular dysplasia and a 2.4-cm aneurysm in the right kidney and uncontrolled hypertension. B, Three-dimensional reconstruction demonstrates location of renal artery aneurysm.

Figure 54–76 A, CT scan demonstrating larger midpolar tumor in a solitary right kidney. B, Three-dimensional arterial reconstruction. C, Kidney on back table in hypothermic solution prior to tumor excision. D, Mass excised with preservation of collecting system and intrarenal arterial tree. E, Contrast enhanced CT scan 4 years later demonstrating no evidence of recurrence.
Although an ileal segment interposition graft can obviate the need for ureteroscopy, the long-term metabolic sequelae are not insignificant (Chung et al, 2006). Autotransplantation, pyelovesicostomy, and a Boari flap can minimize reflux and allow passage of stones (Olsson and Idelson, 1980).
Autotransplantation is an acceptable option for complicated tumors in solitary kidneys and bilateral malignancies. A pyelovesicostomy is recommended to facilitate easy surveillance. Patients with traumatic arterial injuries can also be treated with autotransplantation.
Preoperative Evaluation and Preparation
In addition to preoperative screening, renal and pelvic anatomy are evaluated with dedicated 3D CT angiography, paying specific attention to the iliac vessels. The hypogastric artery and associated branches are ideal conduits for complex multiple-vessel repairs given their size, which is similar to the native renal artery branches. Renal functional scans (e.g., MAG3) should document at least 15% to 25% of the global renal function before surgery. Kidneys with extensive small vessel disease and compromised parenchyma are limited by poor flow dynamics and decreased filtration capabilities and are not candidates for renal autotransplantation. Patients with chronic renal insufficiency or solitary kidneys must consent for placement of vascular dialysis catheters before surgery, and the authors’ nephrology colleagues are made aware of this procedure.
Surgical Procedure
The advantages of renal bench surgery include a bloodless field and optimal exposure of the vascular tree and collecting systems. The ideal length of cold ischemic time should be no greater than 5 to 6 hours. Ex-vivo repair also allows the integrity of the anastomosis to be tested before reimplantation. The technical aspects of bench surgery are demanding and should be performed in high-volume centers with surgeons experienced in vascular and transplantation surgery. The authors prefer a flank approach for an adrenal-sparing donor nephrectomy with preservation of the proximal one third of the ureter. The kidney is completely mobilized and vessel loops passed around the main renal artery and vein. Renal vessels and ureter are dissected to provide maximum length (Fig. 54–77). Mannitol may be given before ligation and division of the vasculature to promote diuresis. Hypothermic University of Wisconsin solution is the authors’ choice for perfusate on removal and initiation of extracorporeal surgery (Belzer et al, 1992). Once the feasibility of the extracorporeal repair has been determined a second team can reposition the patient supine and expose the ipsilateral fossa for reimplantation via a Gibson incision. A single midline incision is another approach that allows access to both operative sites and keeps the ureter in continuity. After the vessels are taken the abdominal wall serves as a bench for microvascular repair or removal of tumor.

Figure 54–77 Nephrectomy for autotransplant is shown. A, Patient is placed in the flank position. An 11th rib supracostal incision maximizes renal exposure. B, Dissection of the left kidney demonstrates exposure of the renal vein to its origin at the vena cava (IVC). C, After ligation of the adrenal and gonadal vessels, the renal vein is mobilized to expose the renal artery. D, Division of the renal vessels is at the origin of the aorta (Ao) and vena cava. The ureter is transected below the pelvic brim. Care is taken not to maintain adventitial tissue or ureter. E, Chilled preservation solution (heparinized lactated Ringer solution) is perfused through the renal artery.
(© The Lahey Clinic.)
Once the renal vessels have been ligated the kidney is flushed with hypothermic solution and placed in an ice-slush solution to minimize ischemia. For vascular anastomosis 5-0 and 6-0 polypropylene is preferred; however, finer suture can be used with surgical magnification. Both native and graft vessels are intermittently flushed with heparinized saline to minimize clot formation. Arterial spasm can be alleviated with papaverine flushes. The integrity of the anastomosis is evaluated with flushing of hypothermic solution (see Figs. 54–78 [on the Expert Consult website![]() ] and 54–79).
] and 54–79).

Figure 54–79 A, Follow-up CT scan 3 years after operation demonstrates good renal function and lack of aneurysm. The patient takes no antihypertensive medication. B, Three-dimensional reconstructions demonstrate no aneurysmal dilation.

Figure 54–78 A, After explantation the aneurysm and associated branching vessels are isolated. B, Tenotomy scissors are used to sharply dissect free the aneurysm, avoiding damage to branching vessels. C, Aneurysm sac is dissected off, leaving room for patch angioplasty. D, Harvested internal iliac patch from reimplantation site is sewn to the artery. E, Internal iliac artery was chosen owing to lower rates of aneurysmal dilation under high pressure, which can occur with vein patch angioplasty. F, Reconstructed renal artery and native vein are reimplanted into the external iliac artery and vein.
For flank approaches a standard curvilinear Gibson incision provides access to the iliac fossa and vessels. Cautious dissection and ligation of surrounding lymphatics is imperative to prevent postoperative lymphocele formation and to minimize the risk of suture line infections. The external vein is mobilized cephalad to the junction where the internal iliac artery crosses over. The venous anastomosis between the renal vein and external iliac vein is completed with continuous or running 5-0 polypropylene in an end-to-side fashion. A disease-free internal iliac artery is anastomosed with continuous or interrupted 6-0 polypropylene to the renal artery end to end. If there is evidence of disease not detected with preoperative imaging then an end-to-side approach is advisable to limit stenosis, recognizing that perfusion pressures may be lower secondary to flow turbulence. Intraoperative ultrasonography can be performed to assess inflow. Surgicel may be wrapped around the anastomosis to ensure hemostasis at needle sites, which tend to ooze once systemic anticoagulation is initiated after surgery. The ureter is reimplanted using an extravesical Grégoire-Lich anastomosis or a Leadbetter-Politano tunneled reimplant using absorbable suture (Figs. 54-80 and 54-81). A psoas hitch and/or Boari flap may be required for extremely short ureters. A 6-Fr transplant double-J stent is next placed across the anastomosis. A Penrose drain or 7-Fr Jackson-Pratt drain is left for 24 to 48 hours.
Postoperative Care and Complications
Elevated lactate dehydrogenase levels can also indicate the presence of a renal infarct. A MAG3 scan can be obtained to evaluate uptake and excretion, but the majority of kidneys repaired ex vivo show immediate and somewhat prolonged periods of acute tubular necrosis. Patients will need to be on systemic heparin therapy during the immediate postoperative period, which increases the risk of hemorrhage and anastomosis rupture. Vascular leaks or thrombosis occur in 1% to 2% of transplants and need urgent surgical revision. Peritransplant fluid collections are of concern and need to be evaluated and treated. Collections discovered between weeks 1 and 3 are usually urinomas and occur in 4% to 5% of transplanted kidneys. Depending on severity they can be managed with revision of the ureteroneocystotomy or stent placement. Fluid collections presenting at 3 to 6 months represent lymphocele formations and occur in 5% to 10% of patients. Presenting symptoms include ureteral obstruction with rising creatinine concentration and iliac vein compression with lower extremity edema. Small lymphoceles can be managed conservatively whereas larger ones require more invasive procedures, such as percutaneous drainage or sclerosing agents. When percutaneous approaches fail, a peritoneal window can be created laparoscopically to facilitate permanent drainage. Patients with infected urine and extravasation can progress to abscess formation, suture line infection, and graft loss.
Outcomes
Numerous investigators have reported acceptable outcomes with extracorporeal surgery and renal autotransplantation. The authors’ success rate is 90% in more than 25 autotransplants, primarily for renovascular disease. Other contemporary series demonstrated similar results with resolution of hypertension in over 90% of patients with preserved or improved renal function, respectively (Jordan et al, 1985; Novick et al, 1990a; Wotkowicz and Libertino, 2004).
These outcomes support the role of autotransplantation for renovascular disease. Numerous case reports and small series demonstrate the feasibility of the procedure for additional indications as listed previously.
Partial Nephrectomy for Benign Disease
In addition to treating malignant disease, which is discussed later in the chapter, partial nephrectomy can also be used for localized benign disease of the kidney (Leach and Lieber, 1980). The indications include hydronephrosis with parenchymal atrophy or atrophic pyelonephritis in a duplicated renal segment; calyceal diverticulum complicated by infection, stones, or both; calculus disease with obstruction of the lower pole calyx or segmental parenchyma disease with impaired drainage (Papathanassiadis and Swinney, 1966; Bates et al, 1981); renovascular hypertension due to segmental parenchymal damage or noncorrectable branch renal artery disease (Aoi et al, 1981; Parrott et al, 1984); traumatic renal injury with irreversible damage to a portion of the kidney (Gibson et al, 1982); and removal of a benign renal tumor, such as an angiomyolipoma or oncocytoma (Maatman et al, 1984).
In a partial nephrectomy for suspected malignancy the renal capsule is excised along with the specimen. In benign disorders a flap of renal capsule can be reflected off the diseased parenchyma and used in renorrhaphy (Figs. 54-82 and 54-83). The remaining techniques are the same as those described for malignant disease.

Figure 54–82 Closure of capsular layer over cut edge of renal parenchyma. Horizontal mattress sutures of 3-0 catgut catch free edges of capsule. View after arterial hemostasis has been completed and after the collecting system has been closed.
(© The Lahey Clinic.)

Figure 54–83 A to D, Technique of transverse renal resection for a benign disorder. The renal capsule from the diseased parenchyma is preserved and used to cover the transected renal surface.
Heminephrectomy can be carried out in a duplicated collecting system. The division between the specimen and what will be remnant parenchyma is evident from atrophy of the diseased segment or can be delineated by pyelotubular backflow after distending the affected collecting system with blue dye. Segmental arterial and venous branches to the diseased portion of the kidney are ligated and divided. Clamping of the artery supplying the nondiseased segment is usually unnecessary. Renorrhaphy proceeds as described for malignancy, although the remnant collecting system in a duplex system will not have been violated and therefore will not require repair.
Stone Surgery
Open surgery for nephrolithiasis is rare, making up less than 2% of stone procedures in contemporary practice (Kerbl et al, 2002; Matlaga and Assimos, 2002). Appropriate candidates for open stone surgery have failed less invasive techniques such as extracorporeal shockwave lithotripsy or endoscopic treatment, have anatomic abnormalities precluding less invasive treatment, or have an exceedingly complex stone array.
Pyelolithotomy
Pyelolithotomy can be effective in removing a small stone burden. This is rarely performed as a solitary procedure because efficacious minimally invasive techniques are more commonly employed. The kidney is approached through a flank or extraperitoneal anterior subcostal incision. The Gerota fascia is opened. The kidney is mobilized within the Gerota fascia and reflected medially to expose the posterior surface. The ureter is located inferiorly and tracked superiorly past the UPJ to the hilum. A U-shaped incision is made on the pelvis, avoiding the UPJ. A forceps is passed through the pyelotomy and is used to remove the stones. A nephroscope also can be employed to inspect the collecting system. A ureteral catheter is passed in an antegrade fashion to ensure that the ureter is free of stone debris. The pelvis is closed with a 4-0 absorbable suture, a Penrose drain is externalized, and the wound is closed in layers.
Extended Pyelolithotomy and Radial Nephrolithotomy
For larger stones and staghorn calculi, a pyelolithotomy can be extended into the sinus after dissecting intrasinus fat away from the pelvis and infundibula. The U-shaped incision will start at the base of an inferior calyx and end at the base of a superior calyx. The stone is separated from the urothelium and removed with forceps. One can dilate an infundibulum to remove a large calyceal component of the stone. In cases in which a calyceal stone is too large to remove through the infundibulum, a radial nephrotomy can be done to extract the stone. The stone is localized by palpation through the capsule, and a radial capsulotomy is sharply made over the stone. The parenchyma is bluntly opened, and the stone is extracted with forceps. The nephrotomy is closed with 2-0 polyglactin suture and Surgicel bolster.
Anatrophic Nephrolithotomy
Knowledge of the segmental renal arterial circulation is fundamental to anatrophic nephrolithotomy. The parenchyma is divided at the border between anterior and posterior vascular segments, permitting removal of complex staghorn calculi.
A supracostal approach is advantageous. The Gerota fascia is opened and the kidney is mobilized. The hilum is sharply dissected, exposing the main renal artery and posterior segmental artery. The renal pelvis and ureter do not need to be mobilized. The arterial branch to the posterior segment is clamped. As the posterior segment whitens, administration of methylene blue permits identification of the border between the anterior and posterior segments, which marks a relatively avascular plane. The line is scored with cautery.
The main renal artery is occluded. The kidney is placed in an ice slush bath and allowed to cool. The capsule is sharply incised along the border between the anterior and posterior segments, being careful to avoid the poles, which have a separate blood supply. The parenchyma is separated bluntly between the anterior and posterior segments. The renal pelvis and calyces are sharply incised, and the stone is removed. Intraoperative ultrasonography, fluoroscopy, and nephroscopy can be employed to ensure stone clearance.
A ureteral stent is placed in an antegrade fashion. The renal pelvis is reapproximated with a running 3-0 monocryl suture. Blood flow is restored to the kidney. Any bleeding vessels are sutured with 2-0 or 3-0 polyglactin. The renal capsule is closed with a running, locking 2-0 polyglactin suture. A Surgicel bolster can be employed. A Penrose drain is externalized through a separate stab excision.
Excision of Simple Renal Cysts
Simple renal cysts are characterized radiographically by thin walls; lack of septation, calcifications, or solid components; and lack of enhancement (Israel and Bosniak, 2005). Asymptomatic cysts are a common incidental radiographic finding. Mass effect from large cysts can cause symptoms or obstruction. Surgical excision of the cyst may be required and is usually handled laparoscopically (Fig. 54–84).
In the unusual circumstance that open surgery is required the kidney is approached through an extraperitoneal flank, dorsal lumbotomy, or anterior approach. The best approach is determined by the size and location of the cyst. After the Gerota fascia is opened, the perirenal fat surrounding the cyst and nearby parenchyma is mobilized. The field is packed to protect surrounding tissues in the event of spillage. A needle is used to aspirate the contents of the cyst, which are sent for cytologic evaluation and culture. The cyst is entered sharply with scissors. The wall of the cyst is excised near normal parenchyma, leaving a few millimeters of cyst wall to be oversewn. Biopsy of the cyst base is performed if there is intraoperative suspicion for malignancy. If frozen section is consistent with malignancy, partial nephrectomy is performed. Otherwise, the cut edges are oversewn with 2-0 polyglactin suture for hemostasis. Cautery is employed as needed and can be used in the spray mode to cauterize the lining of the cyst. For infected cysts, a drain is externalized.
Open Nephrostomy
With the widespread adoption of percutaneous nephrostomy drainage and endoscopic placement of ureteral stents, open insertion of a nephrostomy tube has become rare. When endoscopic and percutaneous approaches have failed, open nephrostomy can be lifesaving (Fig. 54–85). A nephrostomy tube may also be inserted as an adjunct to an open reconstructive procedure such as pyeloplasty or ureterocalicostomy (Willscher and Conway, 1987).
The kidney is approached through a retroperitoneal flank incision. The Gerota fascia is opened laterally. The kidney is mobilized within the Gerota fascia and reflected medially to expose the posterior surface. The ureter is located inferiorly. Dissection proceeds superiorly along the ureter to the renal pelvis. Two 2-0 polyglactin stay sutures are placed in the renal pelvis a safe distance away from the UPJ. With a hooked scalpel, a 2-cm incision is made parallel to the long axis of the kidney between the holding sutures, avoiding the UPJ.
A silk suture is passed through the tip of a Malecot catheter. A Randall stone forceps is passed through the pyelotomy into a lower pole calyx. The tip of the forceps is aimed at the convex border of the kidney, because a nephrostomy on the anterior or posterior surface of the kidney has a higher risk of hemorrhage from damage to intrarenal vessels. While pressure is applied with the forceps, the tip of the forceps is palpated at the convex border of the kidney. A radial capsulotomy is made over the tip of the forceps. The tract through the parenchyma is widened slightly by opening the forceps, which is then used to grasp the silk suture. The forceps is gently withdrawn back through the pyelotomy, while reducing the wings of the Malecot catheter by pulling on the distal aspect of the tube. The tube is thus drawn through the tract, placing the tip in the lower calyx. The silk suture is removed. Rather than using a curved clamp and a Malecot catheter, one can use a Willscher nephrostomy tube, which is equipped with a stylet to puncture the parenchyma.
The tube is sutured to the renal capsule using a 3-0 absorbable purse-string or figure-of-eight suture. The tube is externalized through a separate anterior flank stab incision, ensuring that the tube does not kink. It should not exit beneath a supine patient.
The pyelotomy is closed with a running 4-0 monocryl suture, and the holding sutures are removed. The nephrostomy tube is secured to the skin using a heavy silk suture. A Penrose drain is placed in the region of the repaired pyelotomy and externalized through an additional stab incision. The wound is closed in layers.
Postoperative care of the tube is directed at prevention and treatment of obstructed drainage. The tube should be gently irrigated if it is not draining appropriately. If irrigation does not restore flow or if irrigant exits around the catheter insertion site, antegrade nephrostography should be performed to assess tube position. It is essential to adequately secure the tube at the skin level to prevent dislodgement. The tube should be replaced under fluoroscopic guidance every 6 to 8 weeks, or more frequently if the patient is prone to stone encrustation.
Renal Biopsy
Since the first description of percutaneous renal biopsy nearly 60 years ago (Iversen and Brun, 1951), the role of open renal biopsy has gradually diminished. Generally, open renal biopsy is indicated when a percutaneous biopsy might be associated with excessive risk, such as in patients with a solitary kidney or uncorrected coagulopathy. Open surgery enables hemostasis and provides more tissue for evaluation than percutaneous biopsy. Laparoscopy also permits hemostasis and should be considered before open surgery. The authors have not performed an open renal biopsy at the Lahey Clinic since 1975.
The kidney is approached through a dorsal lumbotomy or subcostal flank incision. The right kidney, which is more inferior, more readily lends itself to biopsy and is preferred. After the Gerota fascia is entered the perirenal fat surrounding the lower pole is mobilized. Two fine absorbable stay sutures are placed in the renal capsule. A third stay suture is placed between them into the parenchyma. An elliptical incision is made in the renal capsule around the third suture, measuring 0.5 to 1.0 cm by 1.0 to 2.0 cm. A wedge biopsy is then performed by deepening the elliptical incision on an angle toward the center of the specimen. The biopsy should include renal cortex and medulla, although deep biopsies risk entry into the collecting system and should be avoided. The capsule is closed primarily using the stay sutures. A Surgicel bolster can be employed. Excellent hemostasis should be assured before the wound is closed in layers.